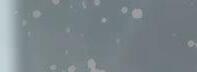

LÉTO 3/2025 bjednávejte do 1 . července 2025.








![]()










LÉTO 3/2025 bjednávejte do 1 . července 2025.











Co to znamená pro vás, naše věrné čtenáře? Ještě více výhod, lepší služby a pohodlnější nakupování.





































Online nákupy se přesouvají na luxor.cz.















































































Budete nově nakupovat na e-shopu luxor.cz, a to za klubové ceny!
• Širší výběr knih i dalšího sortimentu.
• Moderní a přehledný web.












































• Rezervace knih online za výhodné ceny a jejich vyzvednutí do 2 hodin na vybrané prodejně.














• Osobní odběr zdarma ve všech 38 knihkupectvích Luxor.









S aplikací Můj Luxor budete mít
svůj čtenářský svět v kapse.
Stáhněte si ji a získejte:
• 10% slevu na první nákup.
• E-knihy a audioknihy ihned ke stažení.


• Upozornění na akce, slevy a novinky, aby vám neunikla žádná lákavá nabídka.
O všech změnách se včas dozvíte. Zůstaňte s námi v kontaktu na webu, sociálních sítích nebo prostřednictvím newsletterů.



















PREMI M,
A 3 0 5



699,AK NÍ CENA




Terry Hayes
ROK KOBYLEK
Strhující příběh z temného světa špionáže, násilí a globálních hrozeb. Hlavní hrdina ane, elitní agent IA, který se specializuje na rizikové mise v extrémně nebezpečných oblastech, kde pravidla neplatí a přežijí jen ti nejzkušenější, je vyslán do nehostinných pohraničních zemí mezi Pákistánem, ránem a Afghánistánem, aby odtud dostal muže, jehož informace mohou zachránit západ před hrozící katastrofou. Místo toho však narazí na nepřítele, jakého dosud nepotkal brilantního a nelítostného protivníka, který se rozhodl přivést svět na pokraj zkázy. ož an rá .
Váz., 760 stran, 14,5 × 22,7 cm
DA045 35 349,-
GN045 35 99,- 559,-







Anders de la Motte, M ns Nilsson
SMRT P ICHÁ Í NA PROHLÍDK

Anders de la Motte, M ns Nilsson
SMRT ÍHÁ NA ARMARK

Anders & Anette de la Motte V


LO IN NA CAPRI
Stockholmský učitel dějepisu Hugo ind přijíždí společně s dalšími severskými turisty na apri užít si pohádkovou, poznávací i oddechovou dovolenou. ájezd organizuje společnost Belmonte Travels a vede jej její majitelka ara Belmonteová. Na okouzlující ostrov však padne stín, poté co je ve vodě pod tesem Salto di Tiberio nalezen mrtvý muž. koho jde a proč má v kapse brožuru Belmonte Travels? Vplížil se do ráje had, nebo je snad mezi cestovateli někdo, kdo nepřijel na apri odpočívat, ale vraždit? ara a Hugo spojí síly a pokusí se přijít této záhadě na kloub... ož a na atoc a. Brož., 448 stran, 12,5 × 20 cm
Jednoho slunného dne je v nově postaveném, moderním domě nalezena mrtvá realitní agentka Jessie Andersonová. Byla to spěšná a tvrdá obchodnice a ně kdo ji zavraždil. Dopadne bystrý stockholmský inspektor Peter Vinston pachatele? 384 stran


GN0454 6 S 6 0 5 399,- 319,-

NOVÁ

GN04 9 399,- 319,-

sterlen, přezdívaný také skandinávská Provence, se topí ve slunečních paprscích a působí poklidněji než kdy jindy.
Přesto i tady udeří smrt: Během jarmarku starožitných a sběratelských věcí je v samém centru dění zavražděn neblaze proslulý překupník uměleckých předmětů... 440 stran
GN04 9 3 399,- 319,-




ateřina Surmanová SLEPÉ CESTY
Do malých městeček se lidé stěhují, aby vychovávali děti v bezpečném, zdravém prostředí.
V malých městečkách se přece nedějí zlé věci, všichni se znají a sousedům se dá věřit. Tak plyne čas a život i v doleně Vodě kousek za Prahou, dokud se nezačne všechno kazit. soby záhadně mizí, obec sužují tragické události, komunitu rozkládá strach a nervozita. Stojí za stěží vysvětlitelnými jevy vláda, armáda či mimozemské civilizace? Seslal snad Bůh na emi apokalypsu? Anebo za nitky v pozadí tahá někdo plně jiný? Ve chvílích krize se vyjevují pravé charaktery. aždý musí ukázat, za co doopravdy stojí...

Váz., 400 stran, 14,4 × 22,7 cm
GN045634 499,- 399,-












M j čtenáři, příteli na dálku, podej mi ruku, bu tak hodn , projdeme se spolu. udy, do lesa a po zarostlé stezce. do že jsou ty dvě ztracené děti My dva. Drž se pevně. Jdeme na Slepé cesty. e srdce,





ateřina Surmanová VEDÁ SE VÍTR
Se strašlivou bouří náhle přichází také smrt...
Brož., 280 stran
ateřina Surmanová
EPOT LESA


ateřina Surmanová




















Mysteri zní thriller pro fanoušky Jozefa ariky.



GN044325 359,- 279,-
Brož., 472 stran GN043280 399,- 319,ateřina Surmanová T I SEKERY

dhalí youtuber pravdu o brutální vraždě?
Brož., 336 stran







GN044794 399,- 319,-




























Městečkem ost reek otřese brutální vražda mladého páru a jejich dvojčat. lo snad o vloupání, které se tragicky zvrtlo? Detektiv Madison Harperová si to nemyslí. dyž totiž dorazí do zchátralého a až strašidelně prázdného domu, zjistí, že oběti nelze identifikovat a z místa činu zmizely všechny jejich osobní věci. Ani výslechy sousedů nepřinesou mnoho informací vypadá to, že rodinka se sotva přistěhovala. Nikdo se s nimi nesetkal, nikdo nezná jejich jména. S objevem dětského trička s nápisem Tatínkova holčička pochopí Madison mrazivou skutečnost: v domě bylo další dítě. am ale zmizelo? ož a ana V o á.
Váz., 400 stran, 13 × 20 cm
GN633599

4 9,- 375,-


isa eganová SMRTÍCÍ NÁDECH
Na Dentonské univerzitě je v bazénu nalezeno tělo plavecké šampionky. jistí detektiv Josie uinnová, proč dívka zemřela? ož a . so á.
Váz., 384 stran, 14,5 × 20,5 cm
GN630294 449,- 359,-

Freida McFadden
ŽÁDNÉ LŽI
Tricia a than hledají dům svých snů. Navštíví i odlehlé sídlo, které patřilo uznávané psychiatričce, jež před lety beze stopy zmizela. Tricia v domě objeví tajnou místnost, kde jsou uloženy všechny nahrávky doktorčiných sezení s pacienty. Při jejich poslechu odkryje děsivý řetězec událostí, které ke zmizení vedly... 248 s. GN045394 3 9,- 299,-




illian Flynnová MI ELÁ
Amy zmizela v den pátého výročí sňatku. Její muž Nick je po sérii nalezených důkazů obviněn z její vraždy. Prohlašuje, že nic nespáchal, Amyini přátelé a zápisky v jejím deníku však tvrdí opak. do má pravdu? Jak ji poznat? A pokud je Nick nevinný, kam se poděla Amy? Napínavý psychologický román byl přeložen do více než 40 jazyků. Brož., 528 stran GN045363 399,- 319,-

Jean eno EMMA
Napětí, špionáž, politické intriky, nečekané zvraty a zničující láska... Debutový román ikony francouzského filmu. ož a r am B m o á.
Váz., 288 stran, 14,5 × 20,5 cm
GN633598 449,- 359,-
obin ook ŠARLATÁNI


Fakultní nemocnice Boston Memorial Hospital je prestižní adresa. několika místností udělala hybridní operační sály budoucnosti, což se zdá jako významný medicínský pokrok tedy až do chvíle, kdy během rutinní operace přijde o život jinak zdravý muž. Noah othauser, čerstvý šéf zdejších rezidentů, má podezření, že se chyby a následné manipulace se zdravotním záznamem pacienta dopustil egocentrický, by špičkový chirurg Mason, který však obviní anestezioložku ondonovou. dyž ovšem začnou přibývat další mrtí související s anestezií, musí se Noah zamyslet nad schopnostmi veškerého lékařského personálu... Brož., 440 s.
GN045481 399,- 319,-


illy Macmillanová PÁD
ivot Nicole a Toma se ze dne na den změní díky výhře ve výši deseti milionů liber. áhy se nastěhují do supermoderní budovy v žasném areálu panství ancaut v loucestershire. Splněný sen se však změní v noční můru, když je Tom zavražděn... 352 str. GN045 5 449,- 359,-
Andre Mayne GÉNI S LO IN
áhadná elektrická bouře uvrhne Manhattan do temnoty, a když se na něj ještě snese prapodivná dusivá mlha, zhroutí se veškerá elektronická komunikace.
Doktor ray a agentka FBI Black oodová musejí spojit síly, aby dokázali odvrátit apokalyptické spiknutí! 320 s. GN0453 6 399,- 319,-











. J. Tudor K Í ÁK
ačalo to na pouti roku 198 , kde dvanáctiletý ddie potkal pana Hallorana ří áka. Ten přivedl ddieho na myšlenku nevinné hry: a pomoci kreseb si mohla jeho parta nechávat vzkazy. Byla to zábava, dokud je obrázky nedovedly k tělu rozřezanému na kusy... Brož., 320 s. GN04530 359,- 279,-
ucinda Berry EDNA NÁS
dyž se iersten, předsedkyně lubu matek ze západního Holly oodu, objeví mrtvá ve vlastním bazénu, je hned jasné, že nešlo o nehodu. Podezření padá na tři ženy. aždá z nich má temná tajemství i motiv pro vraždu. Jak vyšetřování postupuje, odhalují se nečekané zrady... 280 s. GN044 44 359,- 279,-





vrah?



ož a ára ro á.
Brož., 336 stran, 12,5 × 20 cm
GN044665

399,- 319,-



dlouho, aby to zjistili...


a st s n otáz , a s ro o a n o m ž zam o at o ra a nto na na t r r ám o o na no t o m s a n r n , t rá s zm tá m z
ás o a o z n m. t, n mž m strn r s n so asn nom n os ost s r o m ra .


Jana umlová redaktorka


Tasha oryell POK D MĚ NE ABI E

Jak dokonalý může být vztah, když je váš partner možná sériový vrah? Hannah má poměrně nudný a nezáživný život. rutiny ji vytrhává až případ zavražděných dívek, do kterého se naprosto ponoří a dopodrobna sleduje každičký detail. Poté co je za zločin zatčen pohledný právník illiam, začne mu psát dopisy. Nejdřív si tak chce jen vybít frustraci... Jenže pak jí illiam odepíše. Hannin zájem přerůstá ze zvědavosti v posedlost a ostatní aspekty jejího života se postupně hroutí. dyž je objevena další mrtvá žena, porota nemá jinou možnost než shledat illiama nevinným. A ačkoli mezi ním a Hannah rychle vznikne zdánlivě perfektní vztah, pořád ji hlodají pochybnosti...


dhalte jejich tajemství... než bude pozdě! Napravená zlodějka lea iceová byla svědkem už tolika zločinů, že je pevně rozhodnutá vést spořádaný život. Netuší však, že její hledání spravedlnosti ji přivede do náruče bohatého anglického džentlmena Jordana Tavistocka. S rostoucí přitažlivostí však roste i nebezpečí. A najednou nezáleží na tom, zda mohou aristokrat a zlodějka najít společné štěstí... ale zda přežijí tak ož a a arr so á. Váz., 288 stran, 11,8 × 22,7 cm




















Poté co je Lucy nalezena, jak se potácí ulicemi, celá od krve své nejlepší kamarádky Savvy, si všichni myslí, že ji zabila. ucy a Savvy byly místní zlatíčka: krásné, chytré a okouzlující. ucy si vzala dokonalého muže s dokonalým domem. To Savvy životem poletovala bez závazků jako motýl, jehož všichni milovali. d oné strašné noci noci, z níž si Lucy nic nepamatuje – uplynulo už pár let a ona se mezitím přestěhovala do os Angeles a začala nový život. Jenže po čase tento neuzavřený případ připomene populární podcast o skutečných zločinech a jeho atraktivní moderátor Ben Owens se rozhodne odhalit Savvyina vraha. ucy se tak musí vrátit na místo, kam se zařekla, že už nikdy nevkročí, aby zjistila pravdu o vraždě své kamarádky. Přestože existuje možnost, že ji spáchala právě ona... ož a ra om ra c no á.
Brož., 368 stran, 12,5 × 20 cm
GN045333


Melissa Adelman
CO VIDĚLI SO SEDI
Sama a Alexis vítají okouzlující sousedé v novém bydlišti s otevřenou náručí. Idylka se však zhroutí, když je jejich soused nalezen mrtvý. Na povrch vyplouvají tajemství... 320 s. GN044109 399,- 199,-

Skladem od 2. 6.


Sandra Brown NÍ K TLAK
Bellamy bylo dvanáct let, když byla její sestra zavražděna. Pachatel nebyl nikdy dopaden. osmnáct let později se Bellamy rozhodne vraha vypátrat...
432 stran
GN044602 459,- 359,-
Havárii malého letadla v kanadské divočině na míle daleko od civilizace přežijí jen dva cestující: usty arlsonová, realitní agentka z Beverly Hills, která nikdy nečelila ničemu nebezpečnějšímu než dopravní špičce v os Angeles, a ooper andry, zahořklý vietnamský veterán s nočními můrami z války a zajateckého tábora. usty je zraněná a sama s mužem, z něhož jde strach. ooper je stejně nepřátelský a nemilosrdný jako hornatý terén, ve kterém uvízli. dyby měli na výběr, šli by každý svou vlastní cestou. Ale nemají. Pokud chtějí přežít, musí zůstat spolu! Spojí tedy své síly proti drsným živlům i dvojici hrdlořezů, na které narazí. Polorozbořená bouda uprostřed lesů jim poskytne kryt před nadcházející zimou. áhy zjistí, že touží po něčem víc než jen po přežití... 256 stran GN559365 299,- 149,-
Kristýna Trpková
ŠMÍRÁK
Dvaašedesátiletý duard přišel před devíti měsíci při tragické dopravní nehodě o manželku.
Nyní žije plně sám na okraji Trudnova, vesnice nedaleko

Pardubic jen on a jeho pudl Akim. Ten je taky jednou z mála památek, které mu na ženu zbyly. dyž v obci začne řádit zákeřný travič psů, pochopitelně ho to nenechává klidným... 248 stran
GN045164

399,- 319,-


Joy Fieldingová
SLEPÁ LI KA
Dusnou červencovou nocí náhle zazní střelba. V nenápadné slepé uličce byl někdo zastřelen. Ale kdo? A proč? Všichni místní obyvatelé tu skrývají nějaké tajemství. aždý má své nezacelené jizvy. A plně všichni mají také přístup ke zbrani... 360 stran
GN043172 399,- 319,-




Patricia ibneyová TA N VE ÍREK
jistí inspektorka ottie Parkerová, kdo zavraždil po večírku sedmnáctiletou dívku ucy? 408 stran
GN045 5 449,- 359,-


Felix Francis VINEN, I NEVINEN
Bill Russell je zrovna na dostizích, když mu policie oznámí, že jeho manželka byla zavražděna.
Dopadne Bill vraha? 304 stran
GN044179 429,- 339,-


Daniel Cole HAVRAN
Detektiv Delaneyová se společně se svým kolegou Ashem pouští po stopách zločince přezdívaného Havran. 288 stran
GN044547 399,- 319,-


Tracy Sierra NO NÍ VET ELEC
a okny domu zuří bouře a matka zůstala sama s dětmi. Dokáže je zachránit před mužem, který se vloupal do domu? Brož., 360 s.
GN044071 399,- 319,-



Felix Francis NA TENKÉM LEDĚ
Dostihy na zamrzlém jezeře nejsou tak nevinné, jak se zdálo. Vypátrá bývalý žokej Miles, co se tam děje? 280 stran
GN044984 399,- 319,-


Jitka udvíková POSLEDNÍ PO DRAV
apitán Baloun už věřil, že se na dovolené ukouše nudou. dosi z místních mu však připomněl starý nevyřešený případ... 336 s.
GN043376 359,- 9,-


Sam Holland PÁN LO TEK









Všichni to už někdy zažili. Plíživý pocit, že na vás někdo zezadu upírá pohled. Slabou ozvěnu kroků někoho, kdo vás pronásleduje. Tohle ale není jen nepříjemná představa. Někde blízko číhá šílenec, který si pečlivě vybírá své oběti. Jakmile se mu ocitnete na mušce, už neuniknete. Myslíte si, že máte svůj život ve svých rukou? Přemýšlejte znovu. Protože on už si pro vás jde a nenechá toho, dokud nevydechnete naposledy. ož . rá . Váz., 416 stran, 14,5 × 22,7 cm GN045415 459,- 359,-














Sam Holland ÍSLO 0
dpočítávání začalo. dá se, že ani vězeňské mříže nezabrání tomu, aby bylo hrůzné dílo sériového vraha dokončeno... 392 stran
GN044637 429,- 339,-
Milí čtenáři, snažila jsem se vytvořit dechberoucí příběh, od kterého se nebudete moct odtrhnout, a vyprávět ho očima postav, které máte rádi. Vždy mě fascinovala představa někoho, kdo psychologicky manipuluje s lidmi až k jejich zkáze. Připadalo mi to děsivě znepokojivé, a tak mě bavilo zkoumat mysl vraha i to, jak se s ním Cara, Griffin a Jamie musejí vypořádat.
Doufám, že si čtení užijete stejně jako já psaní!
Sam Holland










Glockner BLÁZNOVA

HROBKA

v Praze, v kufru objeví mrt-
Do zapadlého městečka v Krušných horách přijíždí Vilém Drozd, detektiv, kterého si najala Klára, manželka zmizelého archiváře. ned druhý den ráno se poblíž městečka najde jeho auto, které nechal v Praze, v kufru objeví mrtvolu své expřítelkyně a na lavičce mrzne jejich pětiletá dcera. Navíc v Praze vyhoří jeho byt. Nezbývá mu než se s dcerou ubytovat u Kláry a pokračovat v pátrání. Zatím se do městečka stahují pochybné existence, pátrající po podzemní chodbě dajně


Agatha hristie PRASKLÉ ZRCADLO Poklidné dny v městečku
St. Mary Mead rozčeří žhavé klepy o slavné herečce Marině Greggové a jejím manželovi, nových obyvatelích místního sídla Gossington all. Nedlouho poté zde uspořádají dobročinný večírek –a jedna z návštěvnic na něm za podivných okolností umírá. Místní policie je bezmocná, tápou i zástupci Scotland ardu. Naštěstí mohou těžit z pozoruhodných postřehů slečny Marplové – a ta se nemýlí... Brož., 264 stran
GN045556
399,- 319,-
ouise Pennyová B ICHO NESTV R

vedoucí k hrobce Edwarda Kelleyho...
Brož., 416 stran, 12, × 2 cm GN045362 399,- 319,-
David Glockner
VRAŽD NA RABŠTEJNĚ
Vincent ora se stává opatrovníkem
Jindřicha lam-Gallase, mladého talentovaného malíře a alkoholika, jehož právě propustili z blázince.
Po Vincentově příjezdu se začnou na zámku dít podivné věci... 416 s. GN044463 459,- 359,-
Colleen Cambridge JEDOVAT
STOPA
Když na koktejlové party, pořádané pro častníky prestižní soutěže v psaní, již organizuje klub slavných autorů detektivek, dojde k vraždě, je to příliš lákavé, než aby hospodyně A. hristie Phyllida odolala a nepustila se do pátrání po pachateli... Brož., 2 s. GN044507 399,- 319,-


Angela Marsonsová SMRTÍCÍ VOL NÍ


Nemine den, aby devítiletý aurent epage nebil na poplach. Podle něj totiž hrozí vesničce Three Pines neustále nějaké strašné nebezpečí, od invaze mimozemš anů přes chodící stromy, okřídlené nestvůry až po dinosaury zahlédnuté na návsi. Jenže všichni včetně Armanda a Reine-Marie Gamachových, kteří te v uebecké vísce bydlí, jsou přesvědčení, že má prostě jen moc bujnou fantazii. Vždy kdo by těm jeho šíleným historkám věřil Avšak když aurent náhle zmizí, najednou se zdá, že aspo v něčem možná nelhal. Tak začíná horečné pátrání po chlapci i po pravdě a to, co při tom vesničané objeví v lese, spustí řetězec událostí, jež vedou k vraždě... 464 stran GN045569 549,- 439,Oliver P tzsch
V obchodním centru se ztratí holčička. Její matku objeví mrtvou o pár hodin později v opuštěné budově. Než si inspektorka Stoneová stihne položit otázku, co za vraždou vězí, naleznou v parku další obě , která zemřela stejným způsobem... 344 s. GN043464 459,- 359,-


KATOVA DCERA A ČARODĚJ
Medik Simon ronwieser a jeho žena Magdalena, katova dcera, se vydali v létě roku 1 na pou do Andechsu. Sotva dorazí do kláštera, je zde zavražděn novic. A zanedlouho poté při neštěstí v jedné dílně zmizí beze stopy i podivínský hodinář fráter Virgilius... Brož., 4 6 stran N 499,- 399,-


























Milí čtenáři, z pražsk ých uli ček a z ostravských zákoutí vás zdraví autoři, kteří spojili své síly, aby vám přinesli detektivní příběh plný napětí, temných tajemství a nečekaných zvratů, jenž vás vtáhne do děje a nepustí. Těšíme se, až se do Perfektního alibi začtete!




David a Vláďa alias „Zlý Urban“

David Urban
OČI ZA OKO, CHRUP ZA ZUB
Strhující detektivní příběh potvrzuje starou známou pravdu, že nic není jenom černobílé... 328 stran
GN045369 399,- 319,-
David Urban VRAŽEDN SPL TKA Na okraji lesa se najde ohořelé luxusní auto. Došlo k nehodě, nebo chce někdo zahladit stopy 312 s. GN044752 399,- 319,-


A. J. inn
KONEC P ÍBĚHU
Expertka na krimi žánr začne rozplétat případ, který je mrazivější než fikce – dvacet let staré zmizení ženy a syna spisovatele detektivních románů. Spáchal spisovatel dokonalý zločin ož o a. Váz., 456 stran, 14,5 × 20,5 cm N 499,- 399,-


Detektivní příběh plný nečekaných zvratů...

Zlý Urban PERFEKTNÍ ALIBI


Praha a Ostrava. V obou velkoměstech dojde k vraždám, které mají jeden společný znak. Pachatel na místě činu zanechal kočičí hlavu. Kriminalisté záhy vytipují více než vhodné podezřelé, ale všichni mají perfektní alibi. Týmy vyšetřovatelů z obou měst se musí spojit a společně se vydat na cestu za odhalením sadistického vraha... V tomto unikátním projektu dochází k propojení dvou spěšných autorů kriminálních románů (Davida Urbana a Vladimíra Zlého) v tvůrčí duo


Zlý Urban. Váz., 328 stran, 14,5 × 20,5 cm GN045590





Kolektiv autorů





vězdy současné české literární scény spojily své síly a připravily pro čtenáře sbírku dechberoucích detektivních příběhů. Ponořte se do temných hlubin světa zločinu, užívejte si rafinované zápletky a nečekaná rozuzlení, zapojte své malé šedé bu ky a pátrejte po pachatelích, jejich motivech a detailech způsobu provedení. I ten sebeopatrnější vrah totiž někde zpravidla udělá chybu. Nebo může zůstat zločin nepotrestán Existují snad situace, kdy zdánlivě ušlechtilé cíle mohou ospravedlnit hrůzný čin V této povídkové sbírce není o napětí ani překvapení nouze a zločinci mohou pocházet z nejnižších vrstev, stejně jako z akademických kruhů...
Váz., 208 stran, 12,5 × 20 cm

GN045534 Skladem od 11. 6. 2025 3 9,- 279,-



Bude čtvrté manželství císaře šťastné?

Jaromír Jindra KAREL IV. Avi non, nebo í





Jaromír Jindra







Iny orentzová
DCERA VANDROVNÍ
APAT K K
ena, dcera vandrovní apatykářky Kláry, se častní cesty knížete riedricha do Benátek. Odvážný kníže se pak s enou vydá do Svaté země... 376 str. GN044702 4 9,- 359,-
KAREL IV.
Pro let dědictví
ísař by rád odkázal budoucímu synovi prosperující Čechy, naráží však na odpor panstva... 336 stran GN044630 3 9,- 279,-
Anna Svídnická umírá při porodu a Karel IV. se opět žení. Po svatbě s Alžbětou Pomořanskou spěchá s korunovací dvouletého Václava na českého krále a svou již čtvrtou ženu dává korunovat až o několik dnů později, což Alžběta přijímá se značnou nelibostí. ísař poté jedná v Avignonu s papežem Urbanem a marně se ho snaží přesvědčit, aby se vrátil do íma. Uvědomuje si, že Kristově církvi hrozí rozkol, ale není v jeho moci nebezpečí odvrátit. Také život na Vildštejně není bez dramatických zvratů. Při přestavbě imíčkovy tvrze je v zemi nalezena ukrytá stará truhla, jejíž záhadný obsah brzy vyvolává nejrůznější spekulace...
Váz., 320 stran, 12 × 20 cm GN045278 3 9,- 279,-


Ken ollett
VEČER A JITRO
Píše se rok 997. Anglie čelí tokům Velšanů na západě a Vikingů na východě. ivot je těžký a ti, kdo mají v rukou moc, ji tvrdě využívají a podrobují si spravedlnost, jak se jim zlíbí. Králova moc je křehká, zákony se vykládají všelijak, a tak vládne v zemi chaos. V tomto nejistém čase vystupují do popředí tři lidé mladý stavitel lodí, normanská šlechtična a schopný mnich. Anglie se nachází na svitu středověku a tito tři lidé se ocitnou v nebezpečném konfliktu s nemilosrdným biskupem, který dělá vše pro to, aby získal moc... Román V r a tro dějově předchází monumentální historické ságy z m , a a n s o 760 stran GN041803 49,- 499,-


ana hitton CÍSA OVA HVĚZDA Rudolf II.
Na barvitém pozadí rudolfínské Prahy a císařského dvora se odehrává vášnivý příběh Rudolfovy životní lásky, krásné Kateřiny Stradové. Čtenáře upoutá také tragický osud alchymisty Kellyho a pohnutý životní děl jeho nadané nevlastní dcery Elizabeth. 168 stran GN044515 299,- 239,-


Elizabeth hadwicková S ATEK LV istorický román z bouřlivého období vlády Jindřicha III. Plantageneta, syna neoblíbeného Jana Bezzemka a Isabely z Angoul me. Na pozadí skutečných historických událostí se odehrává příběh dvorní dámy Joanny a nevlastního králova bratra illiama de Valence, kteří uzavřou manželství z politických a majetkových důvodů, okolnosti války je však záhy donutí stát při sobě proti nepřátelům a společně bojovat o přežití... 504 s. GN043643 499,- 399,-


Vlastimil Vondruška LUCEMBURSKÁ
EPOPEJ IV
Otec vlasti (1356–1378)
Čtvrtý díl románové fresky začíná návratem římského císaře z Itálie domů. Je pánem podstatné části křes anského světa a zasahuje do záležitostí církve i jiných panovníků. Dokáže urovnat vleklé spory, jiné ale svou politikou vyvolává. To samozřejmě znamená politické stupky spojencům a také spoustu peněz. Jeho obrovská říše zatím dokáže tyto náklady nést. Představa jednotného světa ho podnítí ke druhé římské jízdě...
Váz., 432 stran, 14,5 × 20,5 cm
GN627088 499,- 399,-
Birgid ankeová
HELENA RUBINSTEINOV


A TAJEMSTVÍ KR S V roce 1 9 vyrazila elena naprosto sama na cestu do Austrálie, kde začala podnikat. Krátce před smrtí se ohlíží za svým pohnutým životem, který ji z největší chudoby zavedl do nejvyšších kruhů newyorské společnosti... 4 stran N 499,- 399,-


Kristina dingová RETA ARBO
Osa ělá boh ně
Greta ovisa Gustafssonová odmalička sní o tom, že se stane velkou filmovou hvězdou. Během studia na prestižní akademii Královského dramatického divadla si zajímavé dívky brzy všimne známý režisér Mauritz Stiller. ascinuje ho její osobnost a svěří jí hlavní roli ve filmu. Tak začala herecká kariéra legendární Grety Garbo... 3 4 stran
N 449,- 359,-





Do áže ře it složit ate atic loh , ale neu í pro evit sv cit

Laura Baldini
Víde , 1932. Erich je ještě chlapec, když se dostane k doktoru ansi Aspergerovi ve víde ské univerzitní nemocnici. Nevidí svět jako ostatní děti. Dokáže řešit vysoce složité matematické lohy, ale neumí projevit své city. Po strašných letech v pěstounské rodině poprvé zažívá náklonnost a porozumění. Zdravotní sestře Viktorine Aspergerův malý žák mimořádně přilne k srdci. A když se průkopnické práce na jejím oddělení zmocní nacistický režim, zhroutí se jí svět. Erich, kterého přemístili na kliniku ve Spiegelgrundu, se ocitá v ohrožení života... ož V t zs a ž . Váz., 2 stran, 12, × 2 cm










N 399,- 319,S lade od





orina Bomannová ANDĚL V BÍLÝCH PL ŠTÍCH
Te n as
Berlín, 1939. Od počátku války musí stát sestry a lékaři v nemocnici aldfriede při sobě. Mladá sebevědomá lékařka se ale jen stěží vypořádává s názory svého šéflékaře na chirurgii, přesvědčeného člena NSDAP. těchu nachází u sympatického zahradníka Tima... ož a . o o á. Váz., 4 stran, 14, × 22,7 cm N 49,- 439,-


orina Bomannová ANDĚL V BÍLÝCH
PL ŠTÍCH
Hvě dná hodina
Berlín, 1919. V okamžiku, kdy se už annah v nemocnici aldfriede cítí jako doma, se ozve minulost... 4 stran N 49,- 439,-
ana hitton RANTIŠEK PALACKÝ
Audioknihu čte oblíbený herec Marek olý. N CD p 299,- ,




sa Avdic O ŽIVOT NAVÍC
Román inspirovaný skutečnými událostmi. Ruth Doranová, vdova a matka tří dcer, se uchází o místo asistentky spiritisty Bradforda, který se snaží odhalit tajemství posmrtného života. Její znalosti a váše pro vědu z ní činí ideální kandidátku, přestože Bradford původně neplánoval zaměstnat ženu. Společně začnou zkoumat možnosti kontaktu s druhou stranou ... Brož., 2 s. N 349,- ,





isa Ridzénová
JE BI T HNOU
NA JIH
Boovi toho v životě nezbývá o moc víc než pravidelné návštěvy pečovatelské služby a věrná psí láska. Podaří se mu napravit ochladlý vztah se synem Váz., 360 str., 13 × 20,5 cm N 449,- 359,-
Jodi Picoultová, J. inney Boylanová OMAMNÝ MED

Anne Jacobsová alias Marie amballe
KAV RNA U ANDĚLA
Nová doba

Alena Mornštajnová ČAS VOS


















Ptáčník se na rozdíl od ní s mi-

Bára a Ptáčník. Dva lidé, jejichž cesty se protnuly dávno předtím, než se ti dva potkali. Bára je přesvědčená, že její život by byl mnohem š astnější, kdyby do něj před lety kdosi nezasáhl a nezměnil jeho směr. Minulost už sice nevrátí, ale může se pokusit přepsat ji v paměti lidí. A taky přemýšlí o pomstě. Zatím však vyčkává, zabydluje se v novém domově a sází květiny. Ptáčník se na rozdíl od ní s minulostí naučil žít. K životu mu stačí svoboda, les a pozorování ptáků. Nebo snad ne Váz., 320 stran, 13,5 × 20,5 cm N 449,- 359,-



Strhující příběh jedné kavárenské dynastie v 1. polovině 20. století. iesbaden, 194 . ilda sotva dokáže uvěřit svému štěstí. Válka skončila a kavárna U Anděla zůstala jako zázrakem ušetřena. Přes všechny překážky chce tento rodinný podnik s bohatou tradicí opět učinit skvělým místem setkávání významných osobností, čímž byl proslulý dříve. Mladý mír však brzy zkalí první konflikty. Když přijde do kavárny půvabná mladá žena a představí se jako její sestřenice uisa, vyvolá to v ildě nedůvěru. Kdo je tahle záhadná uisa, která se z Východního Pruska dostala až do iesbadenu Narůstající rivalita mezi ženami ohrožuje harmonickou atmosféru v kavárně, dokud ilda i uisa nakonec nepochopí, že mají cosi společného – tajemství z válečné doby, jež je dodnes děsí... První díl šestidílné ságy. Brož., 392 stran N 3 9,- 279,-


Oliviin život se rozpadl, poté co její navenek dokonalý manžel odhalil svou temnou stránku. Ani ve snu by ji však nenapadlo, že se vrátí do svého rodného městečka, bude žít v domě, kde vyrostla, a s láskou se věnovat včelaření. Brzy nato se do stejného města přistěhují ily a její matka. Oliviin syn Asher se do ily záhy zamiluje... 480 stran N 499,- 399,Jan Vavřík


Napínavý román s kriminálními prvky se odehrává ve francouzské vesnici, kterou opřádá stín minulosti v osobě Jeana Mazeta. Během druhé světové války sloužil v Paříži jako četník a musel se z častnit deportace židovského obyvatelstva v roce 1942. V obci jej všichni mají za válečného zločince. Podaří se Mazetově vnučce Isabelle dědečka rehabilitovat 384 stran
N 399,- 319,-
Pavlína Křivánková CHALUPA
elenino dítě se dere na svět, ale po jejím příteli se slehla zem. Tereza se potýká s vyčpělým vztahem a dcerou, které nerozumí. ivoty žen přetrhne krutá událost a příběhy se protnou... 280 s. N 329,- 259,enka Potůčková N VRAT NEŽ DOUCÍ




Mladá zdravotní sestra se vrací domů z koncentráku. U Dráž an se k ní přidá nemluvící děvčátko. V pohraničí obě najdou nový domov, přátele i lásku... 408 stran N 399,- 319,-


Nicholas Sparks
JEN P R Z ZRAK
Tanner ughes je armádní ranger, celý život strávil v zahraničí a je nejš astnější, když se může vydat za dalším dobrodružstvím. Po smrti babičky mu však v hlavě rezonují její poslední slova Zjisti, kam patříš. Tanner se proto vydává do Asheboro v Severní Karolíně, kde se záhy seznámí s Kaitlyn ooperovou, lékařkou a svobodnou matkou. Oba cítí okamžité souznění. Jenže Tanner ví, že musí za pár týdnů odjet... 3 2 stran
GN045267 399,- 319,-

Barbara Erskinová SP DAČI
Píše se rok 7 7 po Kristu. V anglosaském království mocné Mercie vládne tvrdou rukou chladný a ctižádostivý král Offa. Jeho třem dcerám je souzeno uzavřít s atky výhodné pro jejich zemi, ale vášnivé srdce nejmladší z nich patří neznámému velšskému princi... Román o ztracené lásce a tajemstvích, jež zůstala pohřbena pod nánosy času a více než tisíc let čekala, až je někdo v 21. století odhalí... 4 stran
GN043018 449,- 359,-




ynthia arrod-Eagles
TAJEMSTVÍ ZÁMKU ASHMORE
V jižní Anglii na svazích malebného dolí řeky Ash stojí majestátní budova zámku, kde sídlí několikátá generace váženého hraběcího rodu Staintonových. istorie rodiny a jejich služebnictva začíná tragickou smrtí lorda Staintona na lovu, po níž se musí ujmout titulu a rodinného majetku nejstarší syn Giles. Giles zjiš uje, že zdědil obrovské dluhy. Aby zachránil panství a postaral se o matku a sourozence, musí se bohatě oženit... 4 stran GN042772 499,- 399,-






Danielle Steel















Rose Mc arthyová, šéfredaktorka jednoho z nejlepších newyorských časopisů, se po smrti manžela ještě více sblížila s dcerami. Nejmladší Nadia má za manžela autora bestsellerů a považuje svůj život za dokonalý, dokud se v bulváru neobjeví zpráva o jeho románku s herečkou. Zlomená Nadia hledá těchu a podporu u své rodiny. Zatímco spolu matka a dcery tráví více času, uvědomují si, na čem v životě nejvíce záleží... ož a c a a o á.
Váz., 2 stran, 12, × 2 cm


GN045358 Skladem od 11. 6. 2025 329,- 259,-
Danielle Steel SOUSEDÉ
Meredith pozve své sousedy, kteří se po zemětřesení ocitnou bez domova, do svého domu. Z neznámých lidí se stávají přátelé... 272 s. GN045356 329,- 259,-
Danielle Steel TEMNÁ STRANA
Po narození dítěte začne Zoe minulost táhnout na okraj děsivé propasti... 2 stran GN043389 299,- 239,-


Danielle Steel SVATEBNÍ ŠATY
Snový život se rozplyne, když novomanželé obdrží zprávu o krachu na burze... 2 stran
GN044778 329,- 259,-






ucy Score
CO JSME NECHALI
ZA SEBOU
Nevrlého milionáře uciana Rollinse a hašteřivou knihovnici Sloane altonovou pojí temné tajemství z minulosti. Zprvu sebou navzájem pohrdají, jejich škádlení se však jednoho dne zvrtne a z jiskry vzplane neuhasitelný požár...
Brož., 4 stran N 499,- ,


enry Turner vždycky věděl, že tře ák na univerzitě nebude procházka růžovým sadem. A bylo mu to jasné ještě dřív, než přijal post kapitána maplehillských Titánů. Ale pak se náhodou připlete do knižního klubu alle Jacobsové a svitne mu naděje. Tihle dva se spolu domluví na vzájemné výpomoci...
ož a arc a á.
Brož., 4 stran, 14, × 22,7 cm N 399,- 319,-







Elsie Silver BEZCITNĚ
Když illa začne dělat chůvu synkovi nabručeného svobodného otce, předpokládá, že vše půjde hladce. Jenže ade je pohledný rančer se širokými rameny, mozolnatýma rukama a pěkně nemravnou pusou. A to je pro děvče z města jako kryptonit...
Brož., 392 stran N 399,- 319,-
Hannah Grace NA LEDĚ
Nathan awkins, hokejista a kapitán maplehillských Titánů, ví, že je odpovědný za to, aby jeho tým zůstal na ledě. Když se však kvůli nedorozumění musí o kluziště najednou dělit s krasobruslaři, ocitne se záhy ve zcela nepředvídatelné situaci... Brož., 44 stran N 399,- 319,-
Rebecca arros D VOD VĚ IT
Učitelka arper miluje děti – jinak by neučila ve školce. Když je potřeba najít nouzovou pěstounskou péči pro předškoláka a jeho bratříčka, rozhodne se je vzít k sobě. Její byt je ale vytopený, a tak skončí v domě své dávné lásky Knoxe... ož a ana a n o á. Brož., 424 stran, 12 × 19, cm N 349,- 279,-
Gigi má tři cíle kvalifikovat se do hokejové reprezentace, získat olympijské zlato a vystoupit ze stínu svého slavného otce. Aby jich dosáhla, potřebuje pomoc od neurvalého ukea. Ten jí nabídne kompromis on jí pomůže dostat se do reprezentace a ona se za něj přimluví u svého táty, u něhož by uke rád získal trenérské místo...
ož a zana a o á. Brož., 2 s., 12, × 2 cm N 399,- 319,-







Ali azelwood
TOHLE NENÍ L SKA
Rue má přátele, na které se může spolehnout, finanční stabilitu, po níž od dětství toužila, a spěšnou kariéru na poli chemických technologií ve společnosti Kline. Její svět je příjemný, tvrdě vydřený a stabilní. Dokud vše neohrozí nepřátelské převzetí firmy v čele s přitažlivým Elim Killgorem... Brož., 3 2 stran N 399,- ,


Jojo Moyesová V CIZÍCH BOT CH
Sam si jen tak tak drží práci a rodina je na ní závislá. Nisha si žije na vysoké noze do chvíle, kdy její muž podá žádost o rozvod. Sam a Nisha by se za normálních okolností nikdy nepotkaly. Když si však omylem vymění tašky v tělocvičně, jejich životy se propletou... Brož., 4 stran N 349,- ,
S lade od


I ta ne apáleně í věd ně se že a ilovat
Jarmila Mlčoušková
Když třeskutou interakci umocní efekt britského přízvuku, i ta nejzapálenější vědkyně může ztratit hlavu pro svého rivala... Nikol je doktorandka v nesnázích. Její výzkumný projekt na Masarykově univerzitě v Brně se zásluhou Alana Parkera řítí do slepé uličky. Zatímco ona si pevně stojí za výsledky svých experimentů, on odmítá připustit, že by udělal chybu ve svých výpočtech. Jejich vzájemná spolupráce hrozí přerůst v rivalitu a vědecký závod kdo s koho, a tak ten namyšlený Angličan přijíždí ověřit svou teorii osobně. Nikol rychle zjistí, že Parker není žádný u ápnutý nerd, který se nechá zastrašit jejím ostrým jazykem... Brož., 264 stran, 12, × 2 cm N 3 9,- ,


Hooverová


Když jednadvacetiletá Auburn Reedová vstoupí do dallaského ateliéru, kam se přišla ucházet o práci, potká charismatického malíře Owena Gentryho. Ten však skrývá tajemství, které by mohlo zničit to nejdůležitější, na čem Auburn v životě záleží. o ale dělat, když rozum velí jinak než srdce ož a ana a o á. Brož., 296 stran, 12, × 2 cm N S lade od 399,- ,












V SRDCI
Samson a Beyah nemají na první pohled nic společného. Přesto se do sebe zamilují... Brož., 336 stran N 379,- ,


Colleen Hooverová N MI TO ZAČÍN
Každý konec má svůj začátek... Pokračování oblíbeného světového bestselleru ám to on Brož., 3 4 stran N 399,- ,


Colleen Hooverová VZPOMÍNK NA NĚJ
Kenna si odseděla pět let ve vězení za tragický omyl. Dá jí okolí druhou šanci Brož., 36 s. N 399,- ,







Lily Gold
SOUSEDSKÁ

VÝPOMOC

Nevěřím vlastním očím, když mi na dveře zaklepou moji tři žhaví sousedi a žádají mě o pomoc. Někdo jim na prahu nechal miminko a oni vůbec netuší, jak se o něj postarat. Po klucích z bytu 5A pokukuju už roky a jako profesionální chůva mám konečně záminku se s nimi poznat líp. Jack je sympatický herní vývojář s nakažlivým směvem. yrus je tanečník, z jehož ladných pohybů mám mozek na kaši. A Sebastian je svalnatý podnikatel s uhrančivým pohledem. Přes den se jim starám o dítě, v noci se zas oni starají o mě. ekla jsem jim, že s láskou nepočítám ale s každým polibkem mám stále větší problém zůstat silná... ož a ana oto á.
Brož., 432 stran, 12,5 × 20 cm



Vi eelandová
PRO EKT É vie po pohovoru zjistí, že si ji její nový šéf vybral jen proto, že se zdá být nejméně schopnou uchazečkou. Výkonná rada firmy ho totiž nutí vytvořit místo terapeuta, o kterého on nestojí. vie ale nehodlá připustit selhání... Brož., 312 stran GN044720 359,- 279,-
mám konečně záminku se



Jen Besser, Shana Feste H Í NÁ DIANA


Diana má skvělou práci, pohledného manžela a dcerku. Ale naplňuje ji to? Manželství poněkud ochladlo, po někdejší vášni není ani památky. dyž se Diana vydá za svou kamarádkou do Santa Fe, probudí se v ní vzpomínky na smyslnou a spontánní ženu, jíž kdysi bývala... Brož., 304 stran GN042613 399,- 319,-





lizabeth oark S ÁBLEM V RÁ I
dyž Dre její expřítel Joel požádá, aby ho doprovodila na rodinný výlet na Havaj, rozhodne se to s ním ještě jednou zkusit. Jenže do jeho rodiny patří také jeho bratr Joshua sexy doktor, který Dre nesnáší... Brož., 376 s. GN044372 399,- 319,-

ladných pohybů mám mozek









GN044989 Skladem od 6. 6. 2025 449,- 359,-
Huang LÁSKA
Alex Volkov je ábel s tváří anděla a s prokletou minulostí, jíž nemůže uniknout. dyž je však okolnostmi přinucen postarat se o sestru svého nejlepšího přítele, začne na hrudi cítit něco nečekaného: heň, který by mohl jeho svět převrátit vzhůru nohama. Ti dva se do sebe nikdy neměli zamilovat ale když se to stalo, na světlo světa vyšla tajemství, která by mohla zničit vše, co je jim drahé... ož a ana r s a.
Váz., 3 2 s., 12 × 1 ,5 cm GN634523 449,- 359,-


VRÁCENÍ
ika byla vždycky poslušná a hodná holka. Ve skrytu duše se však nejednou toužila utrhnout ze řetězu. A vždycky ji to táhlo k bratrovi jejího přítele, Michaelovi, ze kterého jí běhá mráz po zádech. Potom ale jedna osudová noc změní život všem z častněným. ika by měla mít strach. Jenže ho nemá... Brož., 464 stran GN045185 399,- 319,-




Christi Caldwellová NA VLNÁCH LÁSKY
Lady Cassia se ukryje na lodi, která vyráží na moře a jejímž kapitánem je známý korzár Nathaniel llsby. Ten se vydává na poslední misi, než splní své vévodské povinnosti dohodnutým sňatkem. Takový je tedy jeho záměr dokud nezjistí, že za nezkušeným členem posádky se skrývá překrásná žena... Brož., 336 stran GN045078 399,- 319,-
Valerie Bo manová PODKONÍ, NEBO
VÉVODA
Rhys Sheffield, vévoda z orthingtonu, se vsadí se svými přáteli, že se bude na domácí sešlosti vydávat za podkoního a nikdo ho neodhalí. Na party však bohužel dorazí jeho expřítelkyně, krásná lady Julianna a hyse pozná. Uvědomí si, že je to ideální příležitost, jak se mu pomstít za zrušení jejich zásnub... 232 s. GN043654 349,- 149,-









Harvey











a považuje ji za čarodějnici.
Temp sta se po brzké smrti matky cítí ve své americké rodině opomíjená a ztrácí se ve vzpomínkách. dyž dospěje, odjíždí do Provence a zakoupí zchátralé sídlo v Sainte- olombe, malém městě, kde její matka vyrostla. Sbližování s místními obyvateli není snadné, zvláště starosta se k ní chová nenávistně a považuje ji za čarodějnici. Temp sta ale nerezignuje, získá si několik přátel a posléze objeví i tajemství své matky, které jí pomůže prolomit ledy. V matčině rodném městečku nachází lásku i domov.
ož a aros a a roma o á. Váz., 368 stran, 12,5 × 20 cm





GN045297 S 4 6 0 5 399,- 319,-
Po deseti letech oddané práce v roli grafické designérky je ily nečekaně propuštěna. A jako každá chytrá žena ví, že lékem na přebytek času je trocha vína a pokec s nejlepší kamarádkou. Jenže druhý den ráno má ily mnohem víc než jen kocovinu. Má plně nový dům a navíc ve Francii!





ož a na B rn .
Brož., 386 str., 14 × 21 cm GN637148 399,- 319,-

Julia Quinnová ALE NÁ MANŽELKA B P
dá se, že ecilie má jen dvě možnosti: stát se starou pannou, nebo se výhodně vdát. ecilie si překvapivě zvolí třetí variantu vydá se za bratrem do Ameriky... Brož., 312 stran GN042799 329,- 259,-





Gillian Harvey MĚSÍC V PROVENCE
Interiérová designérka Nicky si doposud dokázala se vším poradit. Dokáže změnit také osud chátrajícího penzionu i jeho majitele a možná i najít štěstí? Má na to jeden měsíc pod žhavým letním francouzským sluncem.

Brož., 352 stran GN614089 39 ,- 199,-






Janna Mac regorová NAPRAVEN VÉVODA
ady Daphne má strávit svátky se svou rodinou. dyž ji však omylem nechají doma samotnou, využije volný čas ke snaze splnit si svůj sen a otevřít domov pro neprovdané matky. kýžený pozemek má ale zájem i vévoda ze Southartu... 320 stran GN044320 399,- 319,-



Kai Azer zjiš uje, že souboj mezi touhou a smyslem pro povinnost může být smrtelný... ož a at na r o á.
Brož., 36 stran, 12, × 2 cm GN044755 449,- ,







Kolektiv autorů

Zažijte chvíle strávené v záři slunce ve společnosti hrdinů povídek od známých českých autorek literatury pro mládež a influencerů.
Váz., 2 stran, 12, × 2 cm
GN045192 399,- 319,-







ážná se v bonusové knize vrací k událostem z B zmocn a odhaluje, co se stalo s Adenou. ož a at na r o á.
Brož., 232 stran, 12, × 2 cm
GN045541 349,- 279,-


ex roucher
istorická komedie o lásce, přátelství a odvaze změnit nejen svůj život, ale i dějiny. ož a . no á.
Brož., 4 stran, 12, × 2 cm
GN045378 399,- 319,-


Lauren Roberts BEZMOCNÁ



Paedyn zachrání cizince, aniž tuší, že to je ilyjský princ. Za odměnu je vybrána do brutální soutěže, která má demonstrovat sílu Elity, jejíž členové mají zvláštní schopnosti. Paedyn je ale Obyčejná... Brož., 2 stran GN045661 9,- ,


arlow
Ella se zamiluje do kluka své mrtvé kamarádky. Zjistí ale, že skrývá tajemství... ož a B. ozs a o á.
Brož., 32 stran, 12, × 2 cm
GN044930 399,- 319,-




hloe alsh Kluci To enu BINDIN
Johnny má všechno, o čem by kluk jeho věku mohl snít. Na ragbyovém hřišti je pro svůj tým nepostradatelný. Má před sebou hvězdnou kariéru. Potom ale potká nesmělou Shannon. Zatímco se potýkají s nepopiratelnou chemií, na obzoru se sbírají překážky, které by mohly jejich vztah zničit... Brož., 7 4 stran
GN044576 99,- 479,-


Třetí díl bestsellerové romantasy série m r m. Bitva vypukla. esta za hranice ochranného štítu prověří každý kousek Violetina důvtipu, štěstí a síly, ale ona udělá cokoli, aby zachránila své milované...
ož a a a o á.
Váz., 632 stran, 14, × 2 , cm
N 99,- ,




Mai Corland
PĚT ZLOMENÝCH ČEPELÍ

Pět z nejprohnanějších a nejnebezpečnějších lidí v říši obdrží tajemnou zakázku zabít božského krále Čuna. Za krutovlády nesmrtelného vladaře se totiž dobře daří jen urozeným pochlebovačům, zatímco prostý lid trpí a řadu nevinných čeká poprava...
ož an roc áz a.
Brož., 496 stran, 12, × 2 cm

N 499,- ,






Inez patří ke smetánce argentinské společnosti devatenáctého století a má všechno, co si jen dívka může přát. Když však dostane zprávu o tragické smrti rodičů v Egyptě, něco se jí na tom nezdá. Vydá se proto do Káhiry hledat odpovědi. ned po příjezdu ji magie vycházející z prstenu, který jí daroval otec, dovede ke zjištění, že se zmizením rodičů to není tak jednoduché, jak jí tvrdil strýc. Jeho nesnesitelně pohledný pomocník Inez neustále hází klacky pod nohy, a aby se dozvěděla pravdu, musí se spolehnout na prastarou magii... ož a V. o naro á. Brož., 44 stran, 12, × 2 cm N 449,- ,
dičů se Vydá Káhiry


Sarah A. Parker KREV
K IŠ LOV HO KVĚTU
Před devatenácti lety jsem byla jako jediná přeživší vytržena ze středu krvavého masakru. Nyní jsem ve svěřenecké péči Velmistra. Vedu jednoduchý život a nikdy nepřekračuji Bezpečnou hranici... i když za to platím neopětovanou láskou k muži, který je pro mě nedostupný... Brož., 12 s. N 479,- ,


Alex Aster
TEMNOSTÍN
Pokračování bestselleru a hitu sociálních sítí toro . Isle se podařilo zlomit kletby, které sužovaly šestici říší, a stala se nově zvolenou vládkyní. Ne všichni vládci ale její vítězství přijali dobře. A zatímco se k její říši blíží jistá smrt, Isla si uvědomuje, že skutečným zrádcem je její srdce... Brož., 432 stran N 499,- ,


Tahereh Mafi
JSEM
ROZT ÍŠTĚN
Juliette se nikoho nedotkla už 2 4 dní. A z dobrého důvodu –její dotyk je totiž smrtící. I svět se potýká s vážnými problémy lidé umírají na vážné nemoci, jídlo je nedostupné, ptáci už nelétají a mraky mají zvláštní barvu. Obnovu napadne, že by se Juliette dala použít jako zbra ... Brož., 296 str. N 399,- ,









Váz., 224 stran, 12, × 2 cm



Čong Serang




SVĚT PODLE SISON






















Jean-Paul Dubois P VOD SLZ
rdinka historického románu Sim Sison přijde za tragických okolností o rodinu a podaří se jí utéct do Spojených států. Tam je ale zneužita německým malířem a po mnoha peripetiích se vrací na rozdělený poloostrov. ivot zasvětí vzdělávání a ženskému aktivismu. Sison představuje zástupkyni poválečné generace korejských žen, které volily riskantní cestu ze země rozvrácené válkou – emigraci na vlastní pěst. Jejich životní zkušenost byla často v rozporu s tradiční morálkou, a to jim následně ztěžovalo návrat do společnosti. ož a . m. Váz., 272 stran, 12, × 2 cm N 399,- ,











Září 19 2 dvacetiletá Severina přijíždí do horské vesnice v Pyrenejích, kde má působit jako dočasná učitelka základní školy. Severina do nového prostředí nezapadá liší se smýšlením, oblékáním i chováním... ož a . n manno á. Váz., 36 stran, 12, × 2 cm
N 449,- ,
Román přináší nevšední téma hrdina Paul vstřelí dvě kulky do hlavy svého otce – ovšem v době, kdy už byl jeho zploditel dva týdny po smrti...
Soud provinilému nařídí roční psychoterapii.
Román o s z je pak příběhem, který Paul vypráví svému psychiatrovi – příběhem frustrovaného muže, který má všechny důvody pro to, aby cítil ke svému otci nenávist. S Paulovým líčením však zárove vstoupíme do řady jiných zajímavých světů, vzdálených zeměpisně i časově, a protože se hlavní dějová linka odehrává ve třicátých letech našeho století, tak i do světa pokročilých technologií umělé inteligence. ož a an ra m o á.
N 3 9,- ,


Bernhard Schlink
OL A
Příběh lásky na pozadí dramatických německých dějin od konce devatenáctého století do sedmdesátých let dvacátého století. Olga je sirotek z chudých poměrů, erbert syn venkovského statkáře –oba se vymykají venkovskému prostředí, ve kterém vyrůstají, a právě jejich jinakost je sblíží... 232 stran N 3 9,- ,


Delphine de Vigan
JEDNOHO PROSINCOV HO VEČERA


Matthieu, pětačtyřicet let, manželka, dvě děti, pohodlný život a najednou chu psát, první román, spěch, dopisy obdivovatelů... Mezi těmito dopisy jsou i ty od Sáry, prodchnuté dávnou vášní, o níž si myslel, že na ni zapomněl. A tyto dopisy všechno změní... 16 stran N 299,- , an Kang NELOUČÍM SE NAVŽD
Kniha slavné nositelky Nobelovy ceny za literaturu an Kang. Poutavý román se vrací až k počátkům Korejské republiky, k masakrům, které se odehrály za vlády prvního prezidenta I Sung-mana – ke krvavému potlačení povstání na ostrově Čedžu... 272 stran N 399,- ,

James Norbury













Ztracená a osamělá Amaya, malé štěně, bloudí hluboko v tichých horách, dokud vše nezmění dramatické setkání s vlkem. Tato neobvyklá dvojice se společně vydává na nezapomenutelnou cestu za svitem luny. Zatímco se protloukají dnem i nocí zimním lesem, naučí se mnohé o lásce, oběti a důležitosti přijímání změn... ož a a m nto á. Váz., 176 stran, 1 ,9 × 23 cm 399,-














James Norbury
CESTA

Panda a drá e askavá knížka, která čtenáři jakéhokoli věku předá poselství starodávné moudrosti, potěší hřejivým humorem a zárove poskytne těchu všem nepokojným duším.


16 stran
GN043840 399,- 319,-

James Norbury


PANDA A DR ČEK
Vychutnejte si uklid ující vliv pandy. Podívejte se na své okolí zvídavým okem dráčka, přítele, který je možná malý, ale zato má velké srdce... Dobrodružství pandy a dráčka jsou inspirována buddhistickou filozofií a spiritualitou. 16 str. GN043054 399,- 319,-
harlie Mackesy
CHLAPEC, KRTEK, LIŠKA A K
Kreslený příběh
Oblíbený příběh h. Mackesyho o společném putování chlapce, krtka, lišky a koně a jejich cestě za domovem provází nádherné barevné ilustrace. 192 stran
GN043706 399,- 319,-





Kateřina Krobová, ucie Macháčková DĚCKO



Sára Zeithammerová SVATÁ





ivot hospodské Aloisie se obrátí vzhůru nohama ve chvíli, kdy se její dceři Kristě zjeví v lese Panna Maria. Třebaže ji krom Kristy nikdo neviděl, zpráva se rychle rozkřikne, do zapomenutého kraje začnou proudit zástupy a zadlužená hospoda konečně prosperuje. Krista je stejnou měrou okolím adorována i nenáviděna. Je Krista lhářka, nebo vizionářka Příběh vychází ze skutečných událostí.
Váz., 360 stran, 12,5 × 20 cm GN044760 399,- 319,-

iterární zpracování stejnojmenného rodinného seriálu České televize přináší napínavý příběh na téma náhradní rodinné péče. Čtyři páry usilují o nenarozené děcko samoživitelky Kláry, která je rozhodnutá najít pro něj na vlastní pěst ty nejlepší rodiče. Jak už to však v životě bývá, všechno se pořádně zkomplikuje... Brož., 312 stran GN045469 349,- 279,-


Petra Dvořáková
Autorka v románu rozbíjí médii zjednodušeně prezentovaný a obecně zažitý obraz mentální anorexie coby hubnutí pro krásu. Zachycuje také provázanost rozvoje anorexie s vážným onemocněním dítěte a dalšími traumaty. Brož., 144 stran, 13, × 2 , cm
GN630273 299,- 239,-
Skladem od 13. 6. 2025


Natália Anto áková DĚLOHA
Selma, žena na prahu třicítky, má v životě dvě pevné konstanty. Práci, na které jí záleží mnohem méně, než by se mohlo na první pohled zdát, a toxický vztah se sebedestruktivním Adamem, v němž je pocit absolutní samoty přítomný stejně intenzivně jako láska. Když k tomu přibude stále hůře ovladatelný vztek, Selma ztrácí pocit léta těžce budované kontroly nad svým životem...
Brož., 2 stran, 12, × 2 cm
GN044715
299,- 239,-
ana rištenská tarková PO KRK V TEPL VODĚ


Autorka literárně zpracovala příběhy, které zažila jako kurátorka pro Romy v sedmdesátých letech minulého století. Jednotlivé povídky propojuje postava Pepiny, kurátorky na Praze 4. Její kancelář je v Nuslích, blízko náměstí Bratří Synků, kde se v upatlaném parčíku scházejí olašští Romové, kteří v té době v Nuslích žili. Pepininými klientkami a hrdinkami mnoha příběhů byly především olašské Romky, na nichž ležela tíha starosti o rodinu. Váz., 184 stran, 12,5 × 20 cm
GN045424










na Praze 4. Její kancelář











Alžběta Stančáková
TVOJE TV S HEBKÝM
ODRAZEM
Kočka za oknem a králík se šachovnicovou srstí. Simulační hry pro starší a zajištěné, spánek ministerského ředníka, prk z vlastní svatby, přestřelka v hotelu Django. Bazén v budově zpravodajství, zapovězená noc s jelenem, ale především ta tvoje – tvář s hebkým odrazem. Alžběta Stančáková, známá doposud především básnickou tvorbou ( o s t m – ena Jiřího Ortena a a a – nominace na Magnesii iteru), ve svých arabeskách přešlapuje mezi politikou a láskou. Brož., 16 stran, 11 × 1 cm
GN045503


Kolektiv autorů
SUDET Ztracený ráj
Povídky o předválečném životě v pohraničí od předních českých spisovatelek a spisovatelů. Sudety jsou dodnes považovány za problematický region, jejž silně poznamenal odsun německého obyvatelstva. o se odehrávalo předtím, než běh věcí v pohraničí nenávratně vykolejil Jednotlivé příběhy na pozadí velkých dějin zachycují spletité osudy obyvatel Sudet a vytvářejí plastický obraz tehdejšího života v mnohonárodnostním pohraničí. Váz., 32 stran, 1 × 2 cm
GN630265 499,- 399,-
Iva Gecková NEJHORŠÍ
DCERA
Do čtyřicetileté


Gábiny by nikdo neřekl, že jako teenager uklízela zvratky po opilém tátovi. Ale i ty nejhorší vzpomínky časem vyblednou a život plyne klidně. Ovšem jen do chvíle, kdy Gábina obdrží zprávu, že otec umírá v nemocnici po předávkování léky... 2 stran
GN045315 329,- 259,-


Karla Kubíková H JOVNA
Příběh o ztrátě svobody a mateřské lásce. Píše se rok 19 . inda, mladá manželka a matka čtyřměsíční holčičky, žije na hájovně, která je součástí vojenského prostoru, v němž jsou umístěni ruští vojáci. Jedné noci změní hloupá legrace nezvaných hostů její osud v tragédii a inda se ocitne ve vězení... 216 stran
GN042608 279,- 219,-









lice jsou městem vyšinutým v prostoru i čase. hybějí dokonce na některých mapách českoněmeckého pohraničí. Místní obyvatelé od nepaměti chovají včely a jejich životy jsou zalité sladkostí. Jenže potom přímo ve městě Němci vybudují koncentrační tábor. Anežka, Běla a elena se v licích narodily. Každá měla své plány, které však přítomnost vojáků a tábora dramaticky promění. A s nimi se změní také jejich charaktery... Váz., 319 stran, 13, × 2 , cm
GN630264 449,- 359,-




Jakuba Katalpa
NĚMCI
421 stran


GN210487 399,- 199,-
Jakuba Katalpa
DOUPĚ
GN279441







Jakuba Katalpa ZUZANIN DECH
3 9 stran
GN375207 419,- 199,-
Mnohovrstevnatý román ze současnosti. 312 stran

3 9,- 149,-























Jana Bernášková T I HODINY LÁSKY




olik času potřebujeme na povrchní setkání nad kafíčkem, kolik na sex a kolik času na lásku? Dokážou se ženy navzájem vytušit, aniž by o sobě věděly? A jak moc může být křehký jeden muž?













Barbara Nesvadbová










olektiv autorů
SL NCE

To vše se dozvíte v příběhu Viktora a arolíny, kteří nechtějí nikomu lhát, ale přesto to dělají na každém kroku. áska je plná rozporů, umí být opojně sladká a zároveň temně černá jako oca- ola. Bu jsi něčí milenka, nebo podváděná manželka. To se často říká, ale co když jsi něco mezi tím? o se stane, když se bude Viktor snažit upřímně milovat a zároveň zůstane zodpovědným mužem domácím? vakne mu z jeho žen, nebo najde svou mužskou sílu?



KARIKAT RA M ŽE ze stavět lásku na zklamání? A kdy se milovaná samota začne měnit v osamělost? atímco nejbližší přítelkyně jsou pevně ukotvené ve svých rodinách, fotografka arla stále jen pozoruje. koumá. A pořád dokola si klade otázku, zda jsou vztahy bližních opravdu tak bez poskvrny, nebo zda každý z nás žije jen svoji vlastní karikaturu. Poutavý román Barbary Nesvadbové je o světě za klíčovou dírkou, o tom, čemu věříme a jak málo spoléháme na vlastní intuici. 192 s. GN045360 299,- 39,-

Váz., 256 stran, 12,5 × 20 cm GN630 63 399,- 3 9,-




A PLÁŽ do by netoužil odletět do teplých krajů lenošit u moře, popíjet koktejly, sbírat mušle a nechat se ovívat přímořským vánkem? Jedenáct českých autorek a autorů poslalo své hrdiny na mořské pláže užít si exotiky, klidu, společného rodinného odpočinku či vzpamatovat se ze životních karambolů. Pohoda se ale může zvrtnout i v idylických kulisách... Ilustrovala Adéla opková. Váz., 200 stran, 14 × 17,8 cm GN0455 359,- 9,-








Rozdělilo je tajemství, spojila je láska...
lára Mandausová KDYŽ NA HORÁCH SVÍTÁ
lára Vlasáková
Marie, která žije v nájmu a přivydělává si hlídáním dětí, vdává dceru. Důchodový věk, nedostatek peněz a pocit, že se stává neviditelnou, ji nutí hledat cesty, jak brát samu sebe zase vážně... 200 stran GN04400 329,- 59,-



Helena, Marie, va a Adéla. Čtyři nerozlučné kamarádky. Společné dětství, dospívání i první lásky. aždá je jiná, přesto do sebe zapadají jako dílky puzzle. Nikdy, nic a nikdo je nemá sílu rozdělit. A přece se to stane. Jejich cesty se na dvacet let rozdělí, aby se náhle protnuly ve chvíli, kdy jde jedné z nich o život...
Váz., 200 stran, 13 × 20 cm
GN04540



ve chvíli, kdy jde jedné z nich o život...


Hana Hřebejková A ŽI Í PADESÁTNICE
dyž se přes člověka převalí páté kulatiny, spousta věcí je najednou jinak. Diety přestávají fungovat. Do hor už nevyběhnete jako kamzík a jako ideální zábava se začínají jevit hry na trénování paměti. Jeden by se z toho zhroutil... 128 s. GN04 934 249,- 99,-
Hana Whitton AK SI
PO ANGLICK
ESAT TRÁVNÍK
Navštivte malebnou anglickou vísku ingston, do níž se autorka před lety přestěhovala. Vyprávění Hany hitton vás pohladí po duši stejně jako pohled na dokonalý hedvábný anglický trávník. 248 stran GN04543 299,- 39,-




Marcela Mlynářová
S NAVIGACÍ OS D Autorka s humorem a nadhledem komentuje dění kolem sebe i ve světě. Nenapodobitelným stylem vypráví o svých pozoruhodných příhodách, o dobrodružných cestách po východních Čechách, elezných horách a ostrově orsika. 224 stran
GN045533 299,- 39,-
ené Melichar

Peter Wright VĚROLÉKA EM V YORKSHIR
Autor vypráví příběhy z vlast ní veterinární praxe a s laskavým nadhledem i suchým humorem líčí život vesnické ho zvěrolékaře. Tato sympatická kniha navazuje na tradici slavného Jamese Herriota. 320 stran GN0430 359,- 9,-



Humorné i tragikomické povídky o mezilidských vztazích, o životě vůbec a také o nečekaných karambolech, které se stávají autorovi, sympatickému smolaři, častěji než komukoli jinému. e svým kolům, které si předsevzal udělat, přistupuje poučeně a zodpovědně, ale téměř vždy se něco zvrtne. A je to čištění větráku v koupelně, dolévání oleje do auta, rozbíjení ledu v sudu na zahradě, výlet na motocyklu, doprovázení rodičů své ženy na vyšetření do nemocnice, snaha o romantický manželský večer nebo psaní cedulek, když mu někdo zabere místo na parkování... Váz., 232 stran, 11,5 × 18,5 cm GN0454 4
e svým kolům, které si předse-












Ano, jsem zoufale nešikovný. Jako neomylný magnet na kalamity čistím větrák v koupelně, peru se s ledem v sudu, dávám nactiutrhačné cedule na auta sousedů, oblažuji svou ženu romantickým večerem… Bohužel, nic z toho, co budete číst, jsem si nevymyslel. Kurýrem, kterým jsem se stal ve druhé části knihy, jsem vloni doopravdy byl. Bohudík jen relativně krátce. Naštěstí pro mě, zákazníky i kurýrní společnost… V poslední třetině vašeho zápasu s mou knihou se všichni potkáme s Brigitou. Jsem si jistý, že ji znáte. Je jednoduchá, mocná, chladnokrevná a svým způsobem krásná. Brigita je vir. Pokud se mi budete škodolibě smát, udělá mi to dobře. Ať se vám hezky čte!





James Herriot
KDYŽ SE VĚROLÉKA OŽENÍ


Nahlédněte podruhé do kouzelného a nezapomenutelného světa Jamese Herriota, nejoblíbenějšího veterináře na světě. Mladý veterinář Herriot se konečně oženil s milovanou Hele nou, ale jinak se v jeho životě moc nezměnilo. Stále pracuje v ordinaci Skeldale House v městečku Darro by, cestuje mezi odlehlými farmami na svazích kopců a maleb nými vesničkami v proměnlivém podnebí orkshire Dales a stará se o jejich čtyřnohé a někdy i dvounohé obyvatele, bojuje s rozmary a tvrdohlavostí svých chlupatých pacientů. Herriotův hluboký soucit, poctivost, humor a láska k životu, lidskému i zvířecímu, z jeho knih vyzařují od první do poslední stránky. Na motivy jeho děl vznikl britský seriál. 415 stran GN05 448,- 35 ,-












Mike epine NAPOLEON







Skutečný příběh Napoleona Bonaparta je právě tak podivuhodný a fascinující, jako je kontroverzní. Napoleon povstal z chaosu a hrůz rancouzské revoluce, aby otřesenému národu nabídl vizi budoucí slávy, cti a návratu do čela Evropy. Tvrdil, že prosazuje libertinské hodnoty revoluce a chce osvobodit celý kontinent, ale vzápětí se nechal korunovat císařem, zahájil kroky k obnovení dědičné monarchie a v celém francouzském impériu znovu
zavedl otroctví...
Váz., 144 stran, 21 × 27 cm




Miloš ořejš COLLOREDO-MANNSFELDOVÉ
Nás rodila ctnost
Tato výpravná publikace přibližuje dějiny rodů olloredů a Mansfeldů i pohnuté osudy členů rodiny olloredo-Mannsfeldů. Popisuje také nejvýznamnější z jejich sídel. 2 stran
GN044474 399,- 319,-


Jaroslav Pánek PETR VOK Z ROŽMBERKA
Kniha významného znalce našich dějin přibližuje život posledního představitele mocného a legendami opředeného rodu Rožmberků. Petr Vok patří mezi významné postavy českých dějin přelomu 1 . a 17. století. Stejně tak mu ale náleží výjimečné místo mezi populárními postavami naší minulosti coby prototypu renesančního kavalíra... 332 str. GN560932 449,- 359,-




ana Kneblová ŽIVOT ZA PRVNÍ
REPUBLIK
První republika existovala jen krátce, ale přesto je toto období nabito zajímavými i dramatickými událostmi. Autorka vypráví o všech oblastech života v té době, o problémech po 1. světové válce, o běžném životě lidí, ale také o spěšných podnikatelích, spisovatelích, sportovcích a filmových hvězdách. 272 stran G N043261 349,- 279,-


Mary Beardová SPQR
Dě in antic ho í a
SP R pokrývá tisíc let římské historie a s barvitými detaily odhaluje, jak ím vyrostl z bezvýznamné osady ve střední Itálii v první globální supervelmoc. Kromě toho vrhá nové světlo na římskou kulturu, od rozvodu vody po demokracii a od otroctví po migraci.
Brož., 624 stran, 13 × 19, cm
GN630210 99,- 559,-


ana Kneblová ZA ČAS NAŠICH PRABABIČEK A PRADĚDEČK
Období 1 90 až 1914 bývá nazýváno Belle po ue . V této knize se seznámíte s tehdejším životem ve městech a na vesnicích. Dozvíte se, jaké technické vynálezy se tehdy prosadily, jakým způsobem naši předci trávili volný čas, jak se uzavírala manželství... 240 stran GN044742 3 9,- 279,-


Blanka Kovaříková PRVNÍ REPUBLIKA
Ja žil hvě d
S autorkou knihy nahlédnete do soukromí filmových a divadelních hvězd, ale také dalších mimořádných osobností –režisérů, tanečnic, výtvarníků, lékařů, sportovky i podnikatelů. Každý z nich byl hvězdou ve svém oboru. Dozvíte se, jaké příběhy prožívali, podíváte se do jejich domovů, šatníků i kuchyní a zjistíte, jak žili za první republiky. 328 stran GN042349 419,- 329,-
Ingrid Sewardová MATKA A J
Příběh Karla III a Alžbět II

Pavel Juřík KORUNOVAČNÍ
KLENOTY


Publikace představuje téměř čtyři desítky nejznámějších i méně známých korunovačních klenotů evropských monarchií, panovníky, kteří je objednali u nejlepších zlatníků, i často nelehkou historii, která je provázela. Nejvýznamnější symboly státnosti dodnes budí ctu i zájem veřejnosti. Tato bohatě ilustrovaná kniha je jejich přehledným a zasvěceným průvodcem. 264 stran GN045302 99,- 479,-



mu kromě matky stáli nejblí-

Autorka, která se britskou královskou rodinou zabývá desítky let, v knize vykresluje životní příběh dvou lidí, navzájem si tak blízkých, a přesto tak rozdílných. Zaměřuje se na klíčové události z Karlova dětství a dospívání a všímá si role, jakou hrála jeho výchova k panovnické funkci a komplikovaný vztah s otcem. Přibližuje i ty, kteří mu kromě matky stáli nejblíže, a už to byla lady Diana, amilla, synové či další osobnosti královské rodiny. Váz., 280 stran, 12,5 × 20 cm GN045296 399,-





M. Pilátová, R. učíková a kolektiv
TAŽNÍ PT CI
Příběh es ho e ilu a i i race
Migrace. V posledních letech zaznívá toto slovo ve veřejném prostoru čím dál častěji. V projevech některých politiků se stává strašákem a hrozbou. Přitom se ale lidé stěhovali do jiných zemí odjakživa, a to z nejrůznějších důvodů. Stejně jako dnes je mohla na cestu vyhnat válka nebo tlak v původní vlasti, ale mohli také vyrazit do světa za lepšími možnostmi či za prací. Za minulého režimu se odcházelo za svobodou na Západ , dnes se cizinci stěhují za svobodou k nám. Začtěte se do životních příběhů exulantů a imigrantů – tažných ptáků... Váz., 152 stran, 23,5 × 25,5 cm N 499,- 399,-


Melanie legg JAPONSK MÝT
Kniha odkrývá svět japonských mýtů, legend a příběhů, z nichž mnohé si lidé vyprávějí již po staletí, představuje ale i ty, které vznikly poměrně nedávno a šíří se prostřednictvím moderních médií. Nechybí ani příběhy o odvážných samurajích, kteří inspirují nejen současné japonské tvůrce, ale i hollywoodské režiséry. 224 stran GN045187 4 9,- 359,-


Denisa Prošková MALÍ K
Svět výtvarného umění byl po staletí uzavřeným pánským klubem. Tato publikace je připomenutím známých, slavných i neprávem zapomínaných osobností, a zárove také průvodcem dějinami umění – od renesance až po současnost. A to nejen v Evropě, ale po celém světě, včetně umělky z řad původních obyvatel kolonizovaných zemí. 224 stran GN044611 499,- 399,-







Pavel Černý AKTA MORÁVEK
Jak skutečně proběhl legendární těk
Morávka a Peltána po drátu vysílačky o se přesně stalo během přestřelky
škpt. Morávka v Karlovce Kde skončily jeho pistole – a kde zbraně výsadkářů z operace Anthropoid A kam se poděla těla (a hlavy) všech těch národních hrdinů Kniha se zaměřuje především na pátrání, výzkumy a rekonstrukce. Popisuje i vyšetřovací pokusy a kriminalistická ohledání míst, kde k událostem došlo, názory soudních lékařů a dalších forenzních odborníků.
Váz., 296 stran, 17 × 24 cm
GN045507
Pavel Černý
MOR VKOVA ZPOVĚ
aneb Věří v Boha a ve sv pistole Audioknihu čtou oblíbení čeští herci Ondřej Vetchý, Jiří Dvořák a ukáš lavica. Režie Vlado Rusko. Délka nahrávky 1 hodin 0 minut.
N CD p 349,- 299,-

ucie Bechynková OPRAVDOV ZLOČIN SPECI L
V další várce toho nejděsivějšího ze světa zločinu najdete hlavně případy, které se do oce ovaného podcastu nedostaly. ucie Bechynková vám tentokrát představí zabijáka zanechávajícího na místě činu vzkazy psané rtěnkou a řadu dalších mrazivých osudů.
Váz., 256 stran, 14,5 × 20,5 cm GN634636 449,- 359,-


499,- 399,-



Marek Brzkovský
etectvo představovalo vždy elitní zbra , a to stíhací ještě v mnohem větším měřítku. Publikace mapuje boje stíhačů za první světové války na všech frontách a až do posledních dnů konfliktu.
Váz., 272 stran, 20 × 23,5 cm
GN045256 499,- 399,-





Martin Brabec
ZAPOMENUT OSUD , ZLOČIN A TAJEMSTVÍ SVĚTOV V LK
Publicista Martin Brabec s pomocí historiků, badatelů a pamětníků pátrá v archivních dokumentech, dohledává svědectví a rekonstruuje příběhy spojené s Čechy a druhou světovou válkou. Připomíná například megalomanské plány na přestavbu Prahy na nacistické město budoucnosti a líčí také dramatické osudy loutkáře J. Skupy... 288 stran
GN043548 399,- 319,-



redy (Alfred) irsch (191 ––1944), nadaný sportovec, učitel a člen židovského skautského hnutí, se narodil v áchách a ve 30. letech emigroval do Prahy, kde vedl sportovní klub židovské mládeže. V roce 1941 byl deportován do Terezína a poté do Osvětimi, kde pomohl založit dětský blok, v němž byly děti alespo částečně chráněné před okolními hrůzami. Zemřel za nejasných okolností v březnu 1944.
Váz., 408 stran, 12,5 × 20 cm
GN045292 499,- 399,-


Petr Macek
ZDENĚK ZELENKA
Ach, ty komedie!
Zdeněk Zelenka, respektovaný tvůrce mnoha oblíbených pohádek, detektivních příběhů, komedií či muzikálů, se v knize ohlíží za svým nevšedním životem a pestrou kariérou režiséra a scenáristy. S humorem přibližuje čtenářům natáčení desítek filmových, televizních a divadelních titulů, na nichž měl možnost spolupracovat s těmi největšími hereckými hvězdami.
Váz., 120 stran, 16,6 × 23,9 cm
GN634859 299,- 239,-



Pro uplatnění slevy předložte u pokladny v Galerii Tančící dům svou členskou kartu Knižního klubu PREMIUM.
Více na www.galerietancicidum.cz.

Robert Vano
ROBERT VANO












sud nepublikovaného osobního





Výpravná publikace dokumentuje sedm dekád fotografova života a jeho uměleckou kariéru. Je sestavena z barevných i černobílých snímků a doplněna o autentický text, který vznikl z rozhovorů s Robertem Vanem. Společně s fotografiemi vypráví poutavý příběh s otevřeným koncem. Velká část snímků pochází z doposud nepublikovaného osobního archivu fotografa a z originálních kinofilmů, které čekaly na znovuobjevení více než padesát let. Váz., 296 stran, 29,5 × 30 cm GN045574 1999,-












Kniha plná neuvěřitelných dobrodružství
Sabine Kueglerová
UŽ NEPLAVU TAM, KDE JSOU
KROKODÝLI



M. Nekola a kolektiv ČESKÝ


MARCO POLO
BOHUMIL
POSPÍŠIL












své uzdravení. Po pěti letech
Sabine Kueglerová se v průběhu života často vrací z Německa do Papuy v Nové Guineji, kde vyrostla. Při jedné z cest onemocní, je považována za nevyléčitelnou, a tak se odhodlá k zoufalému pokusu o svou záchranu. Odjede do džungle, aby našla své uzdravení. Po pěti letech plných neuvěřitelných dobrodružství se rozhodne vyprávět o svém hledání léku a identity mezi dvěma kulturami.
Brož., 272 stran, 14 × 21 cm GN045046 399,- 319,-
Za první republiky patřil přerovský rodák Bohumil Pospíšil (1902–1974) k nadějným československým cestovatelům. Na dobrodružném putování kolem světa strávil pět let, napsal o tom množství poutavých článků a dva cestopisy. Když se však v polovině třicátých let odstěhoval na Nový Zéland, jeho stopy mizí. Díky rozsáhlé osobní pozůstalosti, včetně stovek unikátních fotografií, kterou do Čech zaslal Pospíšilův vnuk až z Aucklandu, dnes máme možnost fascinující osudy tohoto světoběžníka zmapovat. Váz., 296 stran, 17 × 23,7 cm GN045536 399,- 319,-




ndřej ment
THR -HIKE
Toužíte po dobrodružství na dálkovém treku, ale nemůžete si dovolit měsíce volna? o takhle týden či dva? Hiker ndřej ment v knize kombinuje inspirativní příběhy z cest s popisem osmi dechberoucích evropských dálkových treků tak, aby mohl vyrazit skutečně každý. Na výběr máte traily přes norské ofoty, Pyreneje a Alpy, přes ostrovy Skye, Island, Madeiru, Tenerife i tropický éunion. ámete si hlavu s výbavou? niha vás provede veškerými základy thru-hikingu: od výběru bot, batohu, spacáku či karimat-


ky přes vrstvení oblečení až po jídelníček.
Váz., 304 stran, 15 × 22 cm











Jan Hocek
ŠUMAVA
Průvodce obsahuje detailní popis bezmála tří desítek jednodenních výletů různé obtížnosti a také jeden vícedenní přechod celkem téměř 00 kilometrů tras. 136 stran GN045011 299,- 239,-


ucie utrová 5 D VOD , PRO NE CESTOVAT S TÁTO PO SKANDINÁVII
Jak to spolu důchodce, třicítka a chlupáč zvládli měsíc ve Skandinávii a co všechno zažili?
1 2 stran
GN044924 359,- 279,-
Denisa Vostrá JAPONSKOU KRAJINOU


A K LT RO Japonsko ve třech týdnech dynamického cestopisu. Japonské speciality, města, muzea, svatyně, obchůdky, horké lázně onsen vše očima otevřenýma dokořán, s důkladnou teoretickou přípravou i se spoustou překvapení. Deník japanoložky Denisy Vostré vás vezme do jokohamského přístavu, do chrámů a svatyní nejen v j tu, nad vodní víry na ikoku... Brož., 248 stran GN044903 359,- 279,-


Ivo Paulík NA KOLE PO
IŽNÍCH ECHÁCH





Jižní Čechy jsou synonymem krajinných i historických krás naší země. blast skýtá i nepřeberné množství tras jako stvořených pro kola a jimi vás provede cestovatel I. Paulík. Výlety si v knize vybere každý, od začátečníků v sedle kola přes rodiny s dětmi až po náročnější výletníky a sportovce. niha obsahuje k dy a PS navigaci. 152 stran GN045150 349,- 279,-











S. hrpová, . ukal, S. auch CHORVATSKEM
NA KOLE
éfredaktorka časopisu Cykloturistika S. hrpová, tvůrce ololodi . ukal a kartograf



S. auch projeli, zmapovali a nafotili celkem dvacet chorvatských regionů na ostrovech, pobřeží i ve vnitrozemí. Výsledkem je průvodce s více než padesáti trasami vhodnými pro cyklisty. Nechybí k dy s mapami tras nebo tipy na výletní cíle a místní gurmánské speciality.
Váz., 168 stran, 1 × 22 cm
GN045564 449,- 359,-


Iveta Toušlová, Josef Maršál
a kolektiv autorů TO LAVÁ KAMERA 40
Víte, kde a kdy vznikla první naučná stezka v Čechách? Nebo jak přišla pražská ampa ke svému jménu? A tušíte, kolik duší má cimbál a k čemu je potřebuje? dpovědi na všechny tyto otázky a spoustu dalších zajímavostí a tipů na výlety vám přináší jubilejní čtyřicátý díl oblíbené Toulavé kamery. V bonusové kapitole navíc nahlédnete do zákulisí výroby oblíbeného pořadu a zavzpomínáte si na jeho začátky.
Váz., 240 stran, 16,5 × 23 cm GN045576 349,- 279,-














Vladimír Soukup, Petr David T EBO SKO NÁMÉ I NE NÁMÉ
Vydejte se do kraje proslulého malebnými rybníky a krásnou přírodou, prozkoumejte zdejší města a městečka, o jejichž bohaté historii vypovídají četné gotické, renesanční i barokní stavby, a už je to klášter a unikátní opevnění v Třeboni, půvabné Nové Hrady, kouzelná lidová architektura či další pamětihodnosti, a ochutnejte rybí speciality!
Váz., 232 s., 16,2 × 24,4 cm
GN045170 399,- 3 9,-


Stanislava Jarolímková P














de stával Jarošův dvorec, jaká byla historie staroměstského smetiště, kdy musela Praha čelit největšímu obléhání a odkdy byly povinné vůdčí listy? To všechno a mnohem více se dozvíme v knize, která nás zve k putování pozoruhodnou historií naší metropole a dovolí nám nahlédnout do dalších pražských okének .










Váz., 256 stran, 12,5 × 20 cm
GN045210 399,- 319,-



NÁMÉ I NE NÁMÉ
Jizerské hory jsou pohostinné, stejně jako lidé, kteří zde žijí. Poj me společně hledat místa známá i neznámá!
232 stran
GN042266 399,- 319,-




Jan Bauer
asvěcený průvodce po oblíbených památkách.
Váz., 264 stran, 12 × 20 cm
GN627084 339,- ,-



olektiv autorů
KNIHA CHEMIE




KNIHA PSYCHOLOGIE

niha vás provede vývojem psychologie a seznámí s nejvýznačnějšími psychology a jejich teoriemi.
360 stran




KNIHA BIOLOGIE
Názorná schémata a diagramy vysvětlují biologické procesy, vše doplňují citáty známých vědců a badatelů i vtipné ilustrace. 336 stran


KNIHA VĚDY

Poutavá publikace představuje nejvýznačnější osobnosti vědy a výstižně objasňuje jejich myšlenky. 352 stran


o je to prvek? Jak se z rostlin vyrábí plast? A proč chemické látky reagují? bjevte a pochopte klíčové myšlenky chemie a seznamte se s jejími významnými osobnostmi.
Váz., 336 stran, 1 ,5 × 23,3 cm
GN045265 99,- 639,-


LIDSKÉ TĚLO V KOSTCE
hromující fotografie a počítačové ilustrace odhalují zcela jedinečným způsobem zázrak lidského těla! Nahlédnete do trob lidského organismu a poznáte jeho fungování zevnitř. dhalíte záhady lidského mozku a pochopíte mnohá tajemství lidského těla... 208 stran
GN045499 599,- 479,-





GN045544 99,- 639,-



KNIHA NÁBOŽENSTVÍ
Další kniha z edice přehledových oborových publikací, určených pro nejširší veřejnost od začátečníků až po odborníky. 352 stran

achel Feder MÝTUS PANA DARCYHO


iterární vědkyně achel
Feder se snaží rozřešit, proč je naše kultura tolik posedlá krutými, citově nedostupnými romantickými hrdiny a občas hrdinkami . Brož., 272 stran
GN044965 399,- 319,-

GN044895 59,- 599,-


adislav paček MALÁ
GN044996 59,- 599,-






KNIHA MATEMATIKY
niha představuje zasvěcený vod do oboru matematiky. Najdete v ní mnoho zajímavého z historie tohoto oboru. 352 stran GN045001 59,- 599,-




GN045020 59,- 599,-



KNIHA MEDICÍNY
Publikace zkoumá a vysvětluje průlomové objevy, které utvářely naše současné chápání medicíny. 336 stran







Váz., 176 stran, 15 × 20 cm
GN045535
GN043943 99,- 559,-



Tato Malá kniha etikety odívání přináší obsáhlý výklad o oblečení pro různé příležitosti, od společenského až po volnočasový styl. Podrobně se zabývá pánskými obleky, košilemi, separátními saky, botami a různými doplňky, stejně tak se věnuje dámskému oblečení, šatům, kostýmům, sukním, halenkám, blůzám, ba i prádlu. Nezapomíná ani na kabáty a klobouky nebo na kravaty a motýlky.

































Karolína Fourová


MOJE PRVNÍ KNIHA O JÍDLE
dravý a pozitivní vztah k jídlu si budujeme už od dětství. A záludné dětské otázky dokážou mnohé rodiče pořádně překvapit. Proč musíme vůbec jíst? A proč to nemohou být jen sladkosti?
Barevným světem jídla a odpovědí provede děti malá Sára se svojí maminkou a mlsným psím kamarádem livou. Ilustrace uke Tomski.
Leporelo, 40 stran, 20,5 × 25 cm GN045443 329,-
























































































Jan Lebeda MEDOVNÍČEK DETEKTIVEM


blíbený skřítek Medovníček tentokrát pomáhá v lese zvířátkům i lidem s řešením záhadných případů.
Váz., 136 stran, 19 × 22 cm
GN044979
329,-


Marta ale ska- ustra PÉŤA ŘÍKÁ DOBROU NOC
Toto krásné, hravé leporelo pomůže dětem nejen s usínáním, ale i s rozvojem řeči. Leporelo, 28 stran, 13,5 × 13,5 cm
GN044910 249,-




va Čepičková HOUBELES A JEHO LES
Skřítek Houbeles vás zve do lesa plného voňavých hub, bylin a roztomilých zvířátek. Poznejte kouzelnou vílu Bilku s vlasy měnícími barvu podle nálady. Pomůže někdo žabce vyčistit studánku? do vydává strašidelné zvuky? Vystopují kamarádi lesní škůdce? V nápaditých kolech za každým příběhem se seznámíte se zvířecími příbytky, tvary listů a druhy hub a zažijete zábavu s půvabnými ilustracemi hrdinů z Houbovce. Ilustrovala Andrea Popprová.
Váz., 56 stran, 20 × 21 cm
GN045419

249,-

duard Petiška, deněk Miler POHÁDKOVÝ
DĚDEČEK
esta vlakem může být pro děti zdlouhavá. Pokud ale dědeček vypravuje pohádky, uběhne jako voda... Ilustroval . Miler.
Váz., 112 stran, 19 × 26 cm
GN045383
299,-


Jóga pro dobré ráno i sladké sny
niha nabízí spoustu j gových pozic s roztomilými ilustracemi, které vám napoví, jak správně cvik provést. Váz., 80 stran, 19,8 × 25 cm GN045307 349,-





















dítě,














lára Dvořáková HERRMANNOVIC HOLKA
vička se narodila do krásných časů první republiky, svět se však začal měnit. Veselá holčička mohla mít život jako každé jiné dítě, ale vzhledem k okolnostem se musela stát silnou a statečnou... Inspirováno skutečným příběhem. Ilustrovala inda Marková. Váz., 48 stran, 21 × 22 cm
GN045506

299,-


duard Petiška, Miroslav ašek SEDM MAMLASŮ
Bylo jednou sedm trpaslíků... totiž Mamlasů. Tehdy to ještě nebylo ošklivé slovo, ale prachobyčejné příjmení jako Dvořák nebo Novák. A kdy že se to pokazilo? To zjistíte v této knize. egendární kniha . Petišky a světoznámého ilustrátora M. aška vychází poprvé od roku 1948.
Váz., 32 stran, 22 × 16 cm
GN045330



















199,-


















KDYŽ NASNĚŽÍ NA SLONY
blíbený básník . rál a světoznámý výtvarník
P. Horáček spojili své síly, aby vytvořili poetickou knihu plnou fantazie, intenzivní smyslovosti i jemných odstínů emocí. Dvacet dva básní propojených s nádhernými obrazy vás provede celým rokem.
Váz., 48 stran, 25 × 25 cm
GN045047 249,-




Váz., 168 stran, 19 × 22 cm




Ivana Fexová TAJNÝ ŽIVOT KOCOURA
Po sérii dobrodružství psích kamarádů Fany a Beryho přichází autorka s příběhy ze světa kočičího. dyž není rodina doma, kocourek Džíno žije tajným životem, někdy nebezpečným, jindy legračním nebo prapodivným. Večer se pak stočí do klubíčka u svých páníčků a těší se, co prožije další den. Pomůžete mu prozkoumávat svět, setkávat se
zvířátky a luštit tajemné hádanky? Ilustrovala ucie Holková.

GN045175 Skladem od 13. 6. 2025 329,-




duard Petiška, deněk Miler JAK SE MARTÍNEK ZTRATIL
Příhody, které Martínek se svými kamarády prožívá, znají všechny děti. aždý se jako malý někdy ztratil, šel poprvé k zubaři...


Váz., 64 stran, 17 × 24 cm
GN044562 199,-

J. ough, J. Field BRUMLA A REMCÍK


Dokonalý svět

rálík emcík je už zase nespokojený!
Jaro je sice tady, ale vůbec neprobíhá podle jeho představ. o emcíkovi zlepší náladu?


Váz., 112 stran, 13,5 × 18,5 cm GN044653 219,-


lára Smolíková MORČATA V AKCI
blíbený komiks o morčatech, která utekla ze zverimexu.
Váz., 60 stran, 21 × 25 cm
GN562927 289,-






Antoine de Saint-Exupéry MALÝ PRINC
Nesmrtelný příběh havarovaného letce a malého prince, plný originálních ilustrací.
Váz., 112 stran, 11,7 × 17,8 cm
GN045528 249,-







Daniela rolupperová
Jarní pohádka lehká jako mávnutí motýlích křídel. Motýlí vílu lvíru postihla nepříjemná nehoda. Dokáže víla s pomocí lidské kamarádky lišky zvládnout nepřízeň osudu? Ilustrovala Ivona nechtlová.
Váz., 80 str., 18,6 × 20,5 cm
GN629007 299,-


Tanya Ste nerová LILI VĚTROPLAŠKA
Tygřice se do lvů nezamilovávají!
ili tráví každou volnou chvíli v zoologické zahradě. Je odvážná a poradí si i s tou nejsložitější situací. A všichni víme, že láska jako trám je věc složitá zvláš když se do sebe bláznivě zamilují tygřice a lev...
Váz., 184 stran, 14,5 × 20,6 cm
GN045520 259,-


achel Pierceyová STARÝ DUB SLAVÍ NAROZENINY
Vydejte se s námi za medvídkem a jeho přáteli!
Váz., 32 stran, 25,6 × 31 cm
GN044240 3 9,-

Hans de Beer LEDNÍ MEDVÍDEK
Nenechávej mě samotného, Larsi!
ední medvídek ars najde v ledové trhlině štěňátko. Pomůže mu najít jeho rodinu?
Váz., 32 stran, 21,5 × 25,8 cm
GN043170 2 9,-









VĚK 8+





omana Suchá MUŠLENČINY LÉČIVÉ PŘÍBĚHY


Třináctá komnata




čelit možným nástrahám. Příběhy jsou zaměřené na témata jako šikana, poruchy příjmu potravy, závislost na mobilu a další. My dospělí často nevíme, jak na to, ale víla Mušlenka zná lék na každé lidské trápení a pomůže dětem lépe pochopit vlastní emoce. Ilustrovala ma Sazama.

Váz., 96 stran, 21,5 × 28 cm




Tentokrát děti společně s laskavou vílou Mušlenkou navštíví třináctou komnatu a posvítí si na temné bytosti, které se tam ukrývají. Tím, že poznají hrozbu s nimi spojenou, budou lépe













GN634642 349,-




























ČESKÝ HONZA
Vybral a upravil
Jiří Horák
Humorné pohádky o chytrém Honzovi ilustroval Josef ada. V knize najdete rozverné vyprávění o tom, jak se stal Honza čarodějníkem, jak šel pro lék, jak se vyučil nebo jak rozesmál princeznu, a mnoho dalších pohádek. Jsou každá jiná, ale jedno mají společné: Honza v nich vtipem a chytrostí vítězí nad protivníky, a už to jsou chamtiví sedláci, lstiví čarodějové, nebo čerti.


Váz., 296 stran, 17 × 24 cm
GN044941 399,319,-




ristina hlssonová
Strašikancelář PŘÍPAD DĚSIVÉHO STÍNU
Napínavá, legrační a strašidelná detektivka!
Váz., 112 stran, 14,8 × 21 cm
GN043913 299,-

inda hapmanová BELLA HLEDÁ DOMOV
Bella je roztomilé a hravé štěně labradora. Dvojčata race a Jack si brzy povšimnou, že tento zvídavý pejsek miluje, když mu někdo předčítá. Pomůže psí láska ke knihám při hledání nového domova?
Váz., 96 stran, 13 × 20 cm
GN044119 299,-





















































































mber nesmírně touží po dobrodružství, jenže v její ospalé vesničce se nikdy nic neděje. Jednoho dne však zachrání z mořského tesu podivného křečka a následně se stane učnicí veterináře magických tvorů. Spolu s velice nepravděpodobným par ákem
vyrazí na důležitou misi: musí zachránit dračí mládě dřív, než mu ze ztráty rodičů pukne srdce! ároveň je však nutné udržet existenci celého tohoto fascinujícího světa v tajnosti, což není vůbec lehký kol. bzvláš když se jim lepí na paty prohnaný padouch koděj Sedmišejdíř, který má s kouzelnými tvory vlastní nekalé plány... ož a . o ro o ná. Brož., 240 stran, 13 × 20 cm GN044954 Skladem od 9. 6. 2025 299,-







ristina hlssonová
Strašikancelář PŘÍPAD CUKRÁTKOVÉ PŘÍŠERY
Ilustrovala Moa allinová.
Váz., 112 stran, 14,8 × 21 cm
GN043914 299,-






























Alena Mornštajnová
STRAŠIDÝLKO
STRÁŠA HASÍ



PRŮŠVIHY
























Strašidýlko Strášu čeká opravdu těžký kol. Musí vypátrat, co je vlastně zač. Je hejkal? Trpaslík? Nejlepší bude, aby Stráša ochutnal od každého ze strašidelnických povolání trochu, a pak se uvidí. A tak se strašidýlko vydává na dobrodružné návštěvy k příbuzným k dědečkovi vodníkovi, ke strýci hejkalovi... terá z profesí nakonec Strášovi padne jako ulitá? Ilustrovala alina Miklínová. Váz., 96 stran, 16,3 × 23,8 cm









GN634634 299,-


























Martin offa PARTA A CESTA PROTI ČASU


Nadia Shireen DĚSOLES
Ať chlupy lítají!


Alastair hisholm
DRAČÍ BOUŘE




Dokážou liščata ubránit svůj nový domov před vetřelcem? Je čas na stromoprásk!
Brož., 256 stran, 15,3 × 1 ,8 cm GN044627 299,-
Kara a Stříbřilapka ara se stane součástí cechu drakovidců, kteří vidí draky a chrání s nimi království...

I na maloměstě se může skupina kamarádů přichomýtnout k napínavým událostem a záhadám, kterým je potřeba přijít na kloub. Jaké tajemství skrývá starý dům plný zachovalých obrazů, zaprášených knih a zapomenutých fotoalb? am se poděla paní, která už několik dní nestojí na svém obvyklém místě za oknem, když jdou děti do školy? První díl série dobrodružství čtyř dvanáctiletých přátel. Pozadí zážitků odvážných členů party nabízí také poučení o temných dobách světových dějin, zeměpise či literatuře. Ilustrovala Barbora Tříletá. Váz., 200 stran, 14 × 21 cm GN043436



















Váz., 144 stran, 12,5 × 20 cm
GN044122 229,-



































Charly Art MĚSÍČNÍ VLCI



Tajemství stínovlků




V roklích Strážných hor se rok co rok scházejí mladí vlci, aby se naučili vše, co potřebuje znát člen smečky. Na cestu se proto vydává i vlče Tamani se svými sourozenci. Jakmile však dorazí na místo, musí obstát v první bitvě: stínovlci si totiž chtějí podmanit všechny ostatní klany. Dokážou se nezkušená mlá ata ubránit?
Brož., 280 stran, 14,5 × 21 cm GN044696 359,-

Jiří Fišar










Brož., 144 str., 16,5 × 21 cm








S partou skvělých kamarádů se i obyčejný den stává výjimečným. do vyhraje v bitvě s mokrou houbou na tabuli? Jak se ve třídě objevila zombie? A kdo v oblíbené počítačové hře získá titul egendární bojovník ? A už se jedná o hraní nejen počítačových her, hledání pokladu, nebo odpolední fotbalový zápas, s Metem, Slívou, Bourákem a dalšími par áky se rozhodně nudit nebudete! Ilustroval Martin Hanschild.

GN045465 299,-








ube id
Stephen Hillenburg SPONGEBOB
Praštěné podmořské příběhy
ož á a.



Brož., 112 stran, 15,2 × 22, cm
GN308161 2 9,-
DENÍK MALÉHO MINECRAFŤÁKA 8
Nejznámější minecraftový vesničan Minus je zpět! ož oman B r .
Brož., 224 stran, 14,5 × 20,5 cm
GN634641 3 9,-





Karl Olsberg VESNICE

V říši Ender draka
Nano a Maffi objeví v temné jeskyni poblíž vesnice zoufalého malého ndermana. Dostanou nového kamaráda zpátky do ndu?
Váz., 160 stran, 14,8 × 21 cm
GN044968 359,-
















































Hidenori usaka POKÉMON 17
Ruby a Sapphire ož at á nton.









Brož., 204 stran, 12,8 × 18,2 cm
GN633279 249,-







Dvacet tisíc blech pod mořem Dogman je zpět! Přečtěte si zbrusu nový komiks z celosvětově nejprodávanější knižní série s oblíbeným psím superhrdinou od autora a ilustrátora Dava Pilkeyho! Nejnovější zápletka známého superzločince je zatím ta nej ábelštější. A další padouchové se možná už rýsují na obzoru. dkud se ale berou? Město potřebuje zachránit! Podaří se to našim jedinečným hrdinům, přestože je sabotují otravní neřádi? ož a V ron a sa o á.
Váz., 240 stran, 14 × 21 cm
GN045120 Skladem od 4. 6. 2025 359,-








Dav Pilkey DOGMAN
Komu letí meruna
Pán blech







Lapač
Váz., 240 stran, 14 × 21 cm

Hidenori usaka POKÉMON


Red a Blue Slavná manga série ze světa Pokémonů! ož . nton.

Brož., 204 stran, 12,8 × 18,2 cm
GN505612 249,-

Váz., 240 stran, 14 × 21 cm
GN043346 359,Dav Pilkey DOGMAN
GN043347 359,Dav Pilkey DOGMAN
Váz., 256 stran, 14 × 21 cm
GN041979 349,-































Tereza Marianová SPOJENCI






















Desetiletý František a jeho děda mají tajemství: americkou helmu, kterou klouček náhodou našel na půdě. Je rok 1984 a o některých věcech se nemluví. Třeba o tom, že Plzeň v roce 1945 osvobodili Američané.
Dědeček Bohumil, pamětník květnových dní, se rozhodl, že je načase říct Františkovi pravdu. A že má co vyprávět!
Proč děda tak miluje čokoládu? Byli v americké armádě indiáni a kovbojové? Jaký byl konec války v západních Čechách? A proč se o tom nesmí mluvit? Bohatě ilustrovaná kniha zaujme malé i větší čtenáře.
Váz., 108 stran, 20 × 26 cm
GN045595


VĚK 6+





Jiří Tomek KRÁL DŽINŮ A DOKONALÁ DÍVKA
Patnáct alžírských, egyptských, syrských, marockých a dalších příběhů vás zavede do světa džinů, princů, kouzelných zrcadel, létajících koberců...
Váz., 224 stran, 17 × 24 cm GN043836 399,-
Vojtěch Mišura CESTA DO ČASŮ KAIROS
David opustí řecké pláže i hádající se rodiče, aby rozluštil tajemství náramku, který našel v Afroditině jeskyni.
Vstupte spolu s ním na místo, kde právě ožívají prastaré báje! Brož., 352 stran, 12,5 × 20 cm
GN044793 299,-


329,-




Uč se triky od profíků! Tato kniha obsahuje medailonky hvězd světového fotbalu a popisy nejzajímavějších technických fines. Díky přehledným ilustracím a názorným textům dokážeš snadno pochopit všech 30 triků. Pak už stačí zajít na hřiště a vyzkoušet je naživo. Brož., 64 stran, 21 × 28 cm GN045603 229,Skladem od 2. 6. 2025








Holger Haag LESNÍ ZVÍŘATA
V životní velikosti
Nádherná publikace obsahuje neuvěřitelně detailní barevné ilustrace a mnoho zajímavostí o patnácti zvířatech. Váz., 56 stran, 24,8 × 34,7 cm GN043205 329,-



Váz., 128 stran, 21 × 24 cm GN045392











Bojový pilot a první český astronaut ti v téhle barvité knížce ukáže, jak to vypadá ve výcvikovém centru, uvnitř stíhačky, mezi mraky a jak se tankuje během letu. Provede tě běžným dnem stíhacího pilota, tréninkem, proletí se s tebou nocí. Představí ti, jak se trénuje na simulátoru nebo jak je náročné manévrovat... Ilustrovala B. Burianová.





J. Němeček a kolektiv KAMARÁDSKÉ
PŘÍBĚHY ČTYŘLÍSTKU
2 7
V knize naleznete dvacet
žasných příběhů.
Váz., 208 s., 21,5 × 30,3 cm


2 6



J. Němeček a kolektiv FANTASTICKÉ PŘÍBĚHY ČTYŘLÍSTKU

omiksová kniha obsahuje

příběhy z čísel 401 až 415 z roku 200 .


Váz., 208 s., 21,5 × 30,3 cm














J. Němeček a kolektiv 4 TAJEMSTVÍ ČTYŘLÍSTKU


GN587042 5 5,-





GN613822 5 5,-






















Připravili jsme pro vás druhé vydání první komiksové knihy z oblíbené edice čtyř příběhů. o z ná a a vám prozradí, jak se Fifinka naučila vařit. Svou chytrost ukáže Myšpulín v příběhu ros n c as rá o c a se stane příležitostí pro Bobíka, aby se stal silným. A v posledním příběhu s názvem ntar t a se Pin a přestane bát. Ilustrace nakreslil J. Němeček. Autory scénářů jsou juba típlová, Hana a Josef amkovi, Jiří Poborák a Jiří Čehovský. Bobík, Myšpulín, Pina a Fifinka vám přejí při četbě této knížky spoustu zábavy!








VĚK





deněk ežák
POLITIKA POLOPATĚ




udmila Bakonyi Selingerová JE MI
SKVĚLE
hceš vědět, jak se cítit skvěle? Tahle knížka plná zábavy, básniček, her, vychytávek a vtipných obrázků ti ukáže, co dělat, když ti není plně hej. niha je určena pro děti, rodiče i pedagogy. az a, 160 stran, 16,5 × 23,5 cm




Váz., 184 stran, 16,5 × 21,5 cm

Jak funguje stát? Proč potřebujeme volby? A co dělá prezident? Tato kniha přibližuje složitý svět politiky pomocí jednoduchých přirovnání. Vysvětluje základy fungování demokracie, rozdíly mezi pravicí a levicí, význam politických stran... Ilustroval ukáš Fibrich.

Váz., 6 stran, 21,5 × 30,3 cm GN629600 390,-




299,- DĚTSKÁ ENCYKLOPEDIE ZVÍŘAT
Prozkoumejte džungle, savany, oceány i polární oblasti. jistěte, jak se zvířata přizpůsobují různým podmínkám a jak se starají o mlá ata. az a, 256 stran, 21 × 26,5 cm
GN044872
Geert-Jan Roebers
Hravá knížka

VODNÍ SVĚT

Brož., 64 stran, 22,3 × 28,5 cm


GN045384 299,-



GN043975


V této knize s krásnými ilustracemi prozkoumáte pomocí hádanek, omalovánek a zábavných kolů vodní svět.
299,-





olektiv autorů
SKA TSKÁ K CHA KA
V
Další z řady skautských kuchařek, tentokrát s recepty, které jsou vymyšlené tak, aby se daly připravit pro větší množství lidí. niha je vhodná pro děti i dospělé. Naučí vás například postavit kamna, zorganizovat si kuchyň i naplánovat jídelníček. Ukáže vám, jak si připravit tábornické klasiky, jako je Setonův hrnec, ale i neotřelé recepty, jako třeba špenátovo-tvarohové knedlíky.
Brož., 1 2 stran, 17 × 24 cm
GN045207
399,- 319,-





Hugo Hromas OHE A D M
Připravte na ohni nejen maso, ale také zeleninové pokrmy, chleba a dezerty! 280 stran GN041719 499,- 399,-





Susann reihe
JEDEN HRNEC –ŽÁDNÉ BYTKY
niha obsahuje recepty, které odkazují na použití standardních velikostí balení čerstvých surovin a díky přesně popsaným postupům v receptech zužitkuje vše beze zbytku! Všechny pokrmy se navíc snadno připravují. 176 stran GN044854 449,- 359,-








Mirka van ils Slavíková V NĚ CHLEBA
spěšná kuchařská kniha od cukrářky M. van ils Slavíkové. hléb byl, je a bude součástí našeho života. Proč si ho tedy neupéct v pohodlí domova? Tato kniha nabízí širokou škálu chutných receptů i klíč k rozpoznání jednotlivých druhů obilovin. 136 stran GN041732 359,- 279,-


olektiv autorů
SKA TSKÁ K CHA KA V
A už jste vedoucí plánující oddílovou výpravu, skupina chystající se na festival, nebo rodiče připravující rodinnou výpravu do divočiny, tato s láskou a péčí sestavená kuchařka je pro vás to pravé. Brož., 6 stran
GN044974 299,- 239,-


365 RECEPT BE C KR
S tři sta šedesáti pěti svěžími recepty a spoustou praktických tipů pro život bez cukru prospějete nejen své postavě, ale také zdraví. 304 stran
GN043867 459,- 359,-




itinový hrnec je skutečným outdoorovým snem. S hrncem dutch oven dokážete připravit téměř cokoli, a to za pomoci žhavých uhlíků, grilu nebo otevřeného ohně. Třeba trhané vepřové, krémové lasagne, pikantní kotlíkové maso, chilli con carne či šneky z listového těsta. Váz., 112 stran, 1 × 24,5 cm




GN045659 399,- 319,-
S 6 0 5











































Josef Maršálek
J. Maršálek sepsal 4 skvělých receptů. Nechte se vést jeho radami a inspirujte se jeho triky!









Martin Svatek
ŽIVOT V K CHYNI
éfkuchař Martin Svatek připravil kuchařskou knihu, která vám ukáže tradiční i moderní recepty, se kterými poznáte ten pravý život v kuchyni! 240 stran
GN045239 549,- 439,-


Váz., 192 stran, 20 × 23 cm



GN630546 549,- 439,-








Dagmar Matějková DELIKÁTNĚ A DRAVĚ BE LEPK
uchařka nabízí jednoduché recepty na vaření bez lepku a je ideální pro každodenní vaření i pečení zdravých jídel. Najdete v ní recepty na předkrmy a svačiny, polévky, hlavní jídla s masem i bez, ale také recepty na pečivo, a už je to chleba, housky, pizza, koláče či dorty. Vše lze snadno připravit bez potřeby vážení stačí pouze hrnek a lžíce nebo lžička. 320 stran
GN045157 549,- 439,-


abriela Peacock MLAD Í A T DNY
námá nutriční specialistka se ve své další knize zabývá dlouhověkostí. Dozvíte se, jak můžete radikálně ovlivnit proces stárnutí. 208 stran
GN044466 449,- 359,-








Filip Sajler, ateřina Černá ILIP SA LER K
éfkuchař, podnikatel, automobilový závodník, televizní hvězda a ikonické recepty jeho kariéry!
Váz., 256 stran, 24 × 28 cm

GN045678



599,- 479,-

Zdravím čtenářky a čtenáře Knižního klubu a doufám, že vám recepty, co s rodinou milujeme, budou chutnat! A taky doufám, že se vám knížka mého života bude líbit.
Filip Sajler







D. Jones, D. Seal






GUSTAV KLIMT
V tvoř si vlastní u ělec dílo


Brož., 96 stran, 2 ,4 × 2 ,4 cm
GN045492


V rabávací obrá MANGA
Milujete mangu Stačí vzít do ruky vyškrabávátko a krok za krokem odkrýt černé vrstvy. Postupně se před vámi objeví krásné, barevné manga motivy. Pomohou vám již viditelné části obrázku a také barevné čáry. Vyškrábaný obrázek můžete poté vystřihnout a darovat. 2 stran
GN045322 249,- 199,-










Vytvořte si vlastní umělecké dílo podle elegantních ilustrací malíře Gustava Klimta, které vám poslouží coby inspirace a průvodce světem secese. Užijte si trochu relaxace s arteterapií. Vytrhněte stránky, abyste se mohli o své výtvory podělit s rodinou a přáteli.
329,- 259,-


ŠV DSKÝCH
K ÍŽOVEK
Kniha švédských křížovek plná lidové moudrosti. Najdete v ní vtipy veselé, smutné, košilaté či děsuplné i ty, nad nimiž zůstává rozum stát. Stačí, když si s tužkou v ruce a s rozumem v hrsti proklestíte cestu spletí písmen, a máte o zábavu postaráno.
Brož., 16 stran
GN045242 1 9,- 119,-


Josef ibický LIBOVK PEP LIBICK HO
Minutový anžel
Rádi tvoříte, renovujete, stavíte nebo opravujete, ale váháte, jak začít Tahle publikace známého kutila a moderátora pořadu ibovky Pepy ibického vám ukáže správný směr. Najdete v ní řadu postupů a mnoho inspirace. Puste se do toho A se vám dílo daří
2 6 stran
GN045547 299,- 239,-






Sabrina Somers AMI URUMI P ÍŠERK DO KAPS
ro to ilých há ovaných i ure do sbír
Tyhle malé amigurumi příšerky jsou tak roztomilé a rychlé na výrobu, že je budete chtít hned všechny uháčkovat V knize najdete 20 jednoduchých návodů.
Brož., 112 stran
GN045245 329,- 259,-



ol
Kolik stejně velkých šesti helníků je zapotřebí k vyplnění prázdného prostoru Jaké číslo chybí v řetězci Které z ozubených kol se zastaví jako první Protrénujte si logické myšlení a vydejte se na dobrodružnou výpravu zákrutami svých mozkových závitů. Kniha obsahuje celkem čtyři sta záludných I loh seřazených podle náročnosti do deseti rovin. Po jednotlivých příčkách se tak postupně vyšplháte až do výšin geniality. Brož., 2 6 stran GN044676 329,- 259,-


Ann Swansonová J A Z POHLEDU
ANATOMIE
Tato kniha na propracovaných ilustracích názorně předvádí mechaniku pohybu, aktivaci svalu, postavení kloubu a vliv jednotlivých fází ásan na průtok krve a dýchání. Ukazuje, jak dosáhnout technické dokonalosti při pravidelném cvičení a optimálně využít výhody j gy pro tělo i mysl. 216 stran
GN041524 499,- 399,-
Theodore Dimon, Jr. ANATOMIE TĚLA V POH BU


Soubor přednášek o kostech, svalech a kloubech, vytvořený nejen pro studenty a terapeuty, ale i pro všechny, kdo se zabývají prací s tělem a pohybem, např. pro tanečníky či pohybové pedagogy. Kniha obsahuje třicet jedna kapitol, z nichž každá se zaměřuje na odlišnou oblast lidského těla. Brož., 264 stran
GN044169 3 9,- 279,-




Šárka Volemanová
MOCI BEZ NEMOCI














Naděje na život je hlavním posláním, které v podobě rozhovorů s renomovanými lékaři, popisem nejčastějších zdravotních diagn z a pacientskými příběhy kniha přináší. Je inspirovaná autorským pořadem árky Volemanové Moci bez nemoci, který vysílá Český rozhlas Dvojka.









Známá moderátorka si díky osobnímu příběhu uvědomila potřebu dávat i ostatním naději ve složitých životních situacích spojených s nemocí. Tak vznikl rozhlasový pořad i tato kniha, kde najdete navíc i praktické informace v podobě možností léčby nebo kontaktů, kde můžete najít pomoc pro návrat do života.



Flexivazba, 176 stran, 14,8 × 21 cm GN045583 399,- 319,-





edvika Jakešová NEJEN O JÍDLE






Plánujete změnu, ale nevíte, kde začít Je důležitější výživa nebo pohyb A když pohyb, tak kolik ho má být Musíte být ve všem precizní, aby měly nové návyky smysl












stoupit z bludného kruhu výčitek, pečovat. Naučíte se, jak mohou obecná doporučení sloužit vám, a ne vy jim
Dá se zdravý životní styl skloubit s běžnými životními překážkami Odpovědi na všechny tyto otázky a další související témata najdete právě v této knize. Už neskočíte na lep předraženým extrémním programům. Povede se vám vystoupit z bludného kruhu výčitek, protože rozpoznáte nevhodné rady, které nemohou fungovat na vaše životní tempo. V kupě nefunkčních trendů společně najdeme, o čem zdraví vlastně je a jak o něj pečovat. Naučíte se, jak mohou obecná doporučení sloužit vám, a ne vy jim Flexivazba, 128 stran, 18,9 × 24,6 cm
GN045214 399,- 319,-


Renata Raduševa erber, Kateřina Svrčinová KOUZELN L K RNA
Minerál a vita in Vitaminy, minerální látky a stopové prvky jsou důležité pro správnou funkci lidského organismu. V knize najdete rady, jak nejdůležitější vitaminy a minerály dopl ovat. 200 stran GN043793 399,- 199,-
D. Vostrá, A. anžlová, R. onzák HROM DO PALICE aneb Ja na ít sv život Kniha od tří Beranů. Zvláštní, že stejné zvíře je symbolem vzpoury i pokory. Ale není i š astný život směsí obojího V knize naleznete rady psychiatra i japonská tradiční okénka. 216 stran GN044834 3 9,- 279,-





NJasmína Houdek, Pavel Houdek TO BYL EN VTIP



399,- 319,-
ažíváte narážky nebo nevhodné vtipy , ale pohotová odpově vás napadne až po deseti minutách? ítíte, že některé situace vás svazují a nutí mlčet, i když byste se chtěli ozvat? Máte někdy pocit, že vás neviditelná sí očekávání a stereotypů brzdí v rozletu? Pak je tahle kniha přesně pro vás! Naučíte se v ní, jak se bránit slovním tokům a manipulaci prakticky, bez omáčky a s humorem. Dozvíte se, jak čelit situacím, kdy vás přerušují na poradách, shazují vaše názory nebo vám podsouvají, že tohle přece není problém . rok za krokem si projdete, jak zvládnout podceňování, shazování, podrývání autority a další běžné jevy, které dusí vaše sebevědomí. A hlavně, naučíte se, jak si svou sílu a hlas vzít zpátky. Tahle kniha není pro ty, co se smíří s tím, že tak to prostě je . Je to manuál pro všechny, kdo chtějí umět zvednout hlas. Pro všechny, kdo chtějí pro sebe a celou společnost lepší budoucnost. Váz., 224 stran, 12,5 × 20 cm GN044 49


Brigid Delaney
BAV SE OBAV
blíbená sloupkařka Brigid Delaney se v tomto srdečném a hlubokomyslném díle, které je plné vřelosti, zabývá tím, jak žít bohatý a smysluplný život. 256 stran
GN0445 3 399,- 319,-


Napoleon Hill
NÁVYKY
SPĚ N CH
niha sestává z rozhovorů s N. Hillem z roku 1952. Dozvíte se v nich mnoho informací o jeho životě a díle v barvitém vyprávění.
192 stran GN045 299,- 239,-
Alex Budak MĚ TO
Tato kniha vás bude inspirovat ke změně, a to k jakékoli změně a už v zaměstnání nebo v osobním životě. Nenabádá vás po sobě spalovat mosty, ale spíše se zamyslet nad tím, jestli v nějakém bodě svého života zbytečně nestagnujete především ze strachu z nějaké konkrétní změny. To můžete přenášet i na ostatní a inspirovat je. Tato myšlenka s sebou přináší zejména kreativitu a akci, což je nejdůležitější obrana proti pasivnímu přístupu, ze kterého plynou většinou jenom negativní závěry. Alex Budak působí na univerzitě v Berkeley a jeho kniha je podepřena různými daty a příkladovými studiemi.
Brož., 328 stran, 12,5 × 20 cm GN0454 4 399,- 319,-


J. Houdek, P. Houdek MODERNÍ SEBEOBRANA
Tato kniha vás naučí poznat své hranice i to, jak si je hájit. Jak použít svůj hlas jako zbraň. Naučí vás, jak předcházet napadení. Jak poznat, že si vás vybírá točník. Jak jednat s člověkem, který vás ohrožuje, a také jak zpacifikovat točníka. 248 stran
GN043 5 399,- 319,-
Maybell e uay ŽABKA RADÍ
Naskočte do této povznášející malé knížky plné pozitivních afirmací o sebelásce a přátelském povzbuzení.


Seznamte se s rozkošným obojživelníkem, který se stane vaším nejlepším přítelem. A už potřebujete emocionální vzpruhu nebo upřímný pohled na svět, žabka bude vaším průvodcem! 96 s. GN044 3 199,- 159,-








Ambika autersová AKRY
Kompletní
Tato kniha vám nabízí možnost otevřít se nové dimenzi zdraví a osobního růstu. abývá se povahou lidského energetického systému a podrobně objasňuje, jak nejlépe umožnit naší energii růst a přetvářet se. 144 stran
GN0449 3 329,- 59,-

Eckhart Tolle MOC
P ÍTOMNÉHO OKAMŽIK
Pracovní kniha
Přítomný okamžik je to jediné opravdové, co v životě můžeme prožívat, a proto bychom se měli naučit ho správně uchopit. niha oc tomn o o amž je jedním z nejznámějších a nejprodávanějších titulů duchovní literatury za posledních několik let. Tato pracovní kniha ji skvěle doplňuje. bsahuje základní teorie, meditace i cvičení. Pokud máte rádi oc tomn o o a mž , pak vám tato pracovní verze nesmí chybět. Brož., 112 str. GN0456 299,- 39,-



Stefanos enakis
DAR
Tato kniha je lékem pro dnešní dobu.
Ve stovce příběhů enakis dokazuje, že radost lze nalézt i v těch nejjednodušších a nejméně očekávaných okamžicích. Tato kniha nás učí, jak milovat a svobodně žít. 280 stran
GN043 9 349,- 9,-

enata aduševa
Herber
KNIHA KO EL A MAGIE NA CEL
ROK
náte pranostiky, zvyky, slavnosti, obřady, rituály a pověry našich předků? Jsou plné moudrosti a zce spjaté se životem... 184 stran
GN04 659 3 9,- 99,-





Hart ig Hausdorf PYRAMIDY SVĚTA


Pyramidy najdeme na všech kontinentech a v nejrůznějších podobách. dá se, že spočítat třeba jen přibližně jejich množství, je nemožný kol. Proč umístily staré národy do krajiny bezpočet těchto staveb? Je snad v pyramidách ukrytá záhadná síla, kterou chtěli mocní využívat? Nebo byli ve hře stavitelé, kteří nepocházeli z tohoto světa? Přinejmenším jedno se zdá být jisté: Na místech, kde jsme je objevili, nestojí náhodou. A možná není planeta emě jediným nebeským tělesem sluneční soustavy, na které tyto tajemstvím obklopené stavby existují...
Váz., 200 stran, 13,5 × 21,3 cm
GN04496 349,- 9,-

Don Miguel uiz MO DROST KNIHY LÁSKA, V TAHY, P ÁTELSTVÍ
Všechno na světě tvoří láska...
V této knize autor shrnuje základní moudrost ze svého bestselleru ás a, zta , á t st a vy se tak můžete rychle seznámit s nejpodstatnějšími myšlenkami, které změní váš život. 6 stran
GN04 4 149,- 9,-



Hart ig Hausdorf MI ELÍ
aždý rok zmizí bezpočet lidí. Většina z nich se zase objeví nebo se pro jejich zmizení najdou přirozená vysvětlení. bývá však znepokojivý zbytek případů, jenž se vymyká racionálnímu vysvětlení... 1 2 stran
GN044344 349,- 9,-









oco Burckhardtová PRVNÍ POMOC V P ÍRODĚ
Vydali jste se do přírody a píchla vás vosa, spálili jste se od sluníčka anebo se poranili o větev První pomoc je hned po ruce – stačí se rozhlédnout a najít tu správnou bylinu. Plané rostliny nám mohou posloužit jako cestovní lékárnička
Brož., 12 stran, 11, × 19 cm











GN045212 299,- 239,-



Anja Kleinová BOHAT RODA Z MAL ZAHRAD
Vypěstujte si vlastní zeleninu, ovoce i květiny
Brož., 144 stran
GN045240 299,- 239,-


hrista einrichová KOMBINOVÁNÍ ROSTLIN
Praktická příručka ukazuje, jak na záhonech kombinovat zeleninu a bylinky. 12 stran
GN043744 299,- 239,-


M. Grabnerová, h. eidenweberová MILUJEME RAJČATA
Odrůdy vhodné na zahradu i balkon. Brož., 16 s.
GN044847 329,- 259,-


rank M. von Berger 150 NEJLEPŠÍCH ROSTLIN
pro ažd stanovi tě
Rostliny snadné na péči, odolné a přátelské vůči hmyzu. Brož., 192 stran
GN044672 3 9,- 279,-







HMYZ
Brož., 192 stran

GN040447 299,- 149,-
HOUB
Brož., 192 stran
GN043433 299,- 149,-

Brož., 216 stran
GN043431 299,- 149,-
STROMY
Brož., 192 stran
GN043432 299,- 149,-
PLANÉ ROSTLINY

Brož., 192 stran
GN040450 299,- 149,-
L ČIV ROSTLIN
Brož., 192 stran
GN043434 299,- 149,-

















Poslední autorský titul legendárního přírodovědce. Kniha, která vznikala téměř sto let. D. Attenborough natáčel ve všech oceánských životních prostředích planety, od ledových moří na p lech po odlehlé korálové tesy. S dlouholetým spolupracovníkem . Butfieldem se dělí o příběh poslední velké divočiny. Nahlédněte do nejhlubších zákoutí nejméně probádaného ekosystému Země Váz., 424 stran, 16,4 × 24,1 cm N 49,- ,








Alethea Morrisonová
VČELA ENÍ
KROK ZA KROKEM
Nápaditě upravená kniha čtivou a názornou formou popisuje, jak si má počínat začínající včelař – od nákupu včelstva až po první sklize medu. Autorka uvádí praktické rady jaké jsou typy lů, kam je umístit, jak je zabezpečit, čistit a chránit před škůdci. Čtenáři se také dozvědí, jaké funkce mají v lu čističky, stavitelky...
Brož., 1 2 stran
N 299,- ,





















Sibylle uise Binderová JAKÝ K SE KE MNĚ HODÍ
Každé plemeno koní je něčím výjimečné a také každý jezdec si svého vysněného koně představuje jinak. hcete si užívat přírody při klidných vyjíž kách Nebo jste ambici znější a toužíte soutěžit na závodech Či jste spíše westernově laděným jezdcem Sibylle uise Binderová vám v publikaci představí, jak se jednotlivá plemena koní liší svým vzhledem, talentem a povahovými vlastnostmi.
Brož., 12 stran, 17 × 24 cm
N 299,- ,
Viola Schillingerová ZAKRSLÝ KR LÍK
Ab se va i vířat dařilo
Jaké druhy králíčků se k sobě hodí, jak by měl vypadat jejich výběh a co mají rádi k jídlu V této publikaci najdete všechny důležité informace. Brož., 1 4 stran N 299,- ,



















































Anita Sch fferová PTAČÍ ZAHRADA Podívejte se, jak uzpůsobit zahradu, aby se u vás okřídleným návštěvníkům líbilo krmítka, pítka, domečky, popeliště, přírodní zákoutí či jezírka... V knize najdete přehršel tipů, jak ze své zahrady udělat ptačí ráj. Brož., 12 s. N 299,- ,


Joyce arol Oatesová BLONDÝNKA
Nesmírně živý, beletrizovaný portrét
M. Monroe. 712 stran
GN043694 499,-


Michaela Grünigová RODINNÝ HOTEL
Bouřlivá doba
Pokračování rodinné
ságy. 384 stran
GN042948 449,-


John Grisham
ČAS
ODPOUŠTĚT
Román od mistra právnických thrillerů. 560 s.
GN043626 449,-



Jana Karšaiová SAMETOVÝ
ROZVOD
Příběh o hledání sebe
sama. 176 stran


GN043749 319,Rosie Goodwin


Charlotte Jacobi PARFUMERIE
DOUGLAS
Vznik rodinného
impéria 368 stran
GN042775 399,-


Jo Spain
POD POVRCHEM
Kdo zavraždil mocného muže v nejchráněnější
budově Irska 440 str.
GN552848 149,-

Spole ní cestovatele
BALI A LOMBOK
Obsáhlý průvodce vám umožní maximálně využít pobyt, oceníte ho před cestou, během návštěvy i po návratu domů. Obsahuje množství barevných fotografií, rady na cestu, tipy na nejvýznamnější památky a zajímavosti, které si nesmíte nechat ujít, i přehledné mapy vybraných míst. Brož., 2 stran GN041495 399,-

DCE IN DĚL
Podaří se Emerald ochránit zadluženou rodinu? 328 stran
GN044093 429,-


Sofia Lundbergová JIN ŽIVOT
Strhující román o touze, vině a přátelství.
312 stran
GN042911 379,-


Audrey J. ole
PILOTOVA DCERA
Thriller pro fanoušky knih Arthura Haileyho! 232 stran
GN044323 329,-


PROVENCE
A AZUROV
POB EŽÍ
Podrobný průvodce. Brož., 224 stran
GN041913 399,-

Anne Jacobsová VENKOVSK
SÍDLO
Zlat as 344 stran
GN040015 399,-


Maria Nikolai ČOKOL DOVNA
Osudová léta Zachrání Viktoria rodinnou firmu? 360 s.
GN042838 449,-


Tom Steinfort
ŠEJKOV H ÍCH
o se skrývá pod nablýskanou fasádou paláce 336 stran
GN043218 359,-



Kate O’Hara Sága rodu
Cald ell
DOLÍ ILUZÍ
376 stran
GN043322 399,-


Sandra Brown SKOK DO NEZN MA
Očistí Thatcher svou pověst 512 stran
GN043737 399,-


Kolektiv autorů HOVOR
S TERAPEUT Poutavé rozhovory s terapeuty. 184 stran
GN042887 359,-

Spole ní cestovatele
TOKIO
Poznávejte svět na vlastní oči Brož., 2 s. GN041553 399,-


enka Poláčková CO ZPÍV SOJKA
istorický román z doby Velkomoravské říše. O adventu roku 3 se na dvoře knížete Svatopluka hoduje. ostem je i Bořivoj, vůdce Čechů, a všechna ta sláva má jediný cíl Přesvědčit ho, aby změnil víru a přijal křest z rukou Metoděje... 296 s. GN043918 299,-


Kolektiv autorů VE ŠKOLE I ZA ŠKOLOU
Povídky českých autorů a autorek. 192 str.


GN044168 359,Dominik andsman NA CHALUPĚ S MODERNÍM OTREM


Dominic Bliss
RAFA NADAL ivotopis jednoho z nejlepších tenistů 21. století. 240 stran
GN043705 359,-


JM Claude KUD L T VÍTR
Vítr děti zavede do různých koutů světa. or o, 16 stran
GN044227 299,-


Eduard Petiška, Helena Zmatlíková
B lo ednou edno
LOUTKOV
DIVADLO 80 stran
GN043677 299,-
160 stran
GN041699 259,-


Volker Dierschke
Nový pr vodce přírodou
PT CI
Brož., 2 6 stran
GN042918 399,-


Jan Diblíček
TVO ÍME
S DIBLIKEM
PRO DĚTI
128 stran
GN044662 359,-


Tracy Reesová R ŽOV
ZAHRADA


Každý dům má své tajemství... Brož., 344 s. GN043854 459,Gill Thompson SESTR OD MAJ KU
áska je jejich světlem ve tmě... 376 stran GN044199 499,-


Juliette Morillotová RUD ORCHIDEJE
ZE ŠAN HAJE
Skutečný příběh korejské dívky. 416 stran
GN043350 499,-


Dmitry Glukhovsky
STANOVIŠTĚ
Na stráži
Postapokalyptická sci-fi. 288 stran


Andreas Gruber VRAŽEDN POH DK


Alessandra Torre VŠECHN MOJE
TOUH
Měla to být jenom
hra... 272 stran
GN599031 379,-


Další případ pro Maartena S. Sneijdera. 464 s. GN042764 499,Romy ausmannová M ŠLENK VRAHA
Od autorky bestselleru t 280 stran GN043228 359,-


GN043425 359,Pavel Juřík KR LOVNA BITEV


Bohatě ilustrovaná publikace. 352 stran GN042862 499,Rudy inka NA CESTĚ DOM
VŽD CK
264 stran
GN042329 499,-


A. Szpunar Přírodohraní na celý ro STAR M SE O PLANETU hceš se dozvědět víc o obnovitelných zdrojích energie Zajímá tě, jak šetřit elektřinou Odpovědi na tyto a jiné otázky najdeš v této žasné knize. A nejen to, kniha je plná zábavných kolů a aktivit Brož., 66 stran GN043646 329,-


Alessandra Torre NEVINNOST SE ZAV ZANÝMA OČIMA
296 stran
GN545009 349,-


James Swallow ODPLATA
Rozkryje bývalý agent MI Marc Dane děsivé spiknutí 472 stran
GN043027 499,-


Martin Vačkář S JAPONSKEM V SRDCI
Odhalte krásu Japonska! Brož., 36 stran GN041858 399,-


A PAND


Tabea Bachová D M HEDV BÍ Intri
Pokračování bestselleru m á 3 4 s.
GN043083 329,-


Daniel Gris ZEMĚ ZMARU
Od autora světového bestselleru a m Lars Brož., 267 stran GN611888 379,-


Shawn Stevenson SP NEK JE UMĚNÍ
Světový bestseller. 376 stran GN044400 399,-


Mark Twain DOBRODRUŽSTVÍ
TOMA SA ERA


R. . Stevenson DOKTOR
JECK LL
Boo alker ŠPANĚLSKÝ ÚSVIT
Baxter se až příliš brzy stane vdovcem. Aby se mohl naplno věnovat své dceři Mie, opustí slibnou hudební kariéru.


Společně se vydávají do panělska. o na ně čeká v zemi vášnivého flamenca 400 stran
GN043722 499,-


T. Gerritsen, G. Braver STUDENTKA
Zjistí inspektorka oomisová, kdo zabil studentku Taryn 32 str. GN042752 399,-


Shawn Stevenson JEZTE CH T E
Třicetidenní program se vzorovým jídelníčkem. 416 stran GN042959 499,-


Veronika ugová KNOOKIN


one Theilsová ŽENA, PO KTER
SE SLEHLA ZEM
Od autorky románu z tra t 296 s.
GN043729 379,-


Thomas ohrer ŠK DCI A CHOROB ROSTLIN
Brož., 3 4 stran
GN042594 399,-


Philip Kiefer
KNIHA
GN042141 299,ans de Beer LEDNÍ MEDVÍDEK
Kouzelný příběh o přátelství. 32 stran GN043169 279,-
Světová četba pro nejmenší. 32 stran GN508305 259,-
A PAN H DE 72 stran GN537533 169,-
Pletení na há u Kniha s přehlednými fotopostupy. Brož., 64 s. GN044243 299,-
LO ICKÝCH H DANEK
208 stran


Sally Rooney INTERMEZZO
Brož., 432 stran, 12, × 1 ,8 cm
GN600446
299,- 239,-










Suzanne Collins SUNRISE ON THE REAPING
Váz., 416 s., 16 × 24 cm
GN614599
499,- 399,-




Stephen King NEVER FLINCH
Váz., 432 stran, 16 × 23,6 cm
GN625409 749,- 599,-


Taylor Jenkins Reid ATMOSPHERE
Brož., 352 s., 15 × 23 cm
GN619402
399,- 319,-
Skladem od 5. 6. 2025


John Grisham FRAMED
Brož., 368 stran, 13, × 1 ,7 cm
GN634114
299,- 239,-


Rebecca Yarros FOURTH WING
Brož., 4 8 stran, 12,8 × 1 ,8 cm
GN577529
349,- 279,-

















Balení obsahuje: plechovou krabičku s 55 kartami. Hra je vhodná pro 2 8 hráčů od let. ozměry balení: 13,3 13,2 5,4 cm.







Materiál: polyester, rozměry: 40 40 4 cm.










GN615106 799,- 639,-





GN614962 439,- 369,-















Baterie 3 AAA nejsou součástí balení. ozměry balení: 18,3 14,4 13,8 cm.
























Balení obsahuje: kartonový podklad s obrazovou předlohou s očíslovanými plochami, sadu akrylových barev, štětec, kartonový stojánek pro kelímky s barvami a rámeček. ozměry balení: 2 ,5 19,9 4,4 cm.










GN598167 519,- 419,-



Balení obsahuje: 2 sklenice výška: cca 15,5 cm, objem: 480 ml . Sklenice nejsou vhodné do myčky.


GN547313 799,- 639,-



GN595261 349,- 279,-




















Balení obsahuje: keramickou misku 530 ml a hůlky. Misku lze mýt v myčce a je vhodná i do mikrovlnné trouby. ozměry balení: 1 ,9 14,1 10,5 cm.








GN616946 399,- 319,-



Disney VILLAINOUS
Být padouchem je fajn! Kdo zvítězí v tomto epickém souboji o zlověstnou moc? Balení obsahuje: 4 říše, 4 figurky padouchů, 120 karet s padouchy, 60 karet osudu, 40 mincí, kotel, 4 referenční karty, 4 průvodce pro padouchy a pravidla hry. Hra je vhodná pro 2–4 hráče od 10 let. Rozměry balení: 26,9 × 26,7 × 6,6 cm. GN613310 1699,- 1359,-






















































HEX IT



Rozměry balení: 10 × 10 × 10 cm.

















Nová blesková postřehová hra. Balení obsahuje: 57 pevných hexových kartiček, se kterými si můžete zahrát pět postřehových her. Hra je vhodná pro 2–6 hráčů od 5 let.



Je čas oběda a psí maminky musí zahnat svá štěňátka domů. Které fence se to povede nejdříve? Jednoduchá zábavná desková hra s ilustracemi Lucie Charvátové. Balení obsahuje: herní plán, 12 žetonů se štěňátky, 4 boudičky, 4 dřevěné figurky pejsků, hrací kostku a pravidla hry. Vyrobeno v ČR. Hra je vhodná pro 2–4 hráče od 4 let. Rozměry balení: 23,4 × 23,1 × 6,4 cm.






NA














GN635556 299,- 239,-





Booster

Omalovánky obsahují 96 stran s nejrůznějšími aktivitami, 2 listy se samolepkami a 6 oboustranných pastelek. To vše v praktickém balení na cesty. Rozměry sady: 25,1 × 28,9 × 1,4 cm.
Jednorožci
GN610891 169,- 129,-







Disney LORCANA ARCHAZIA’S ISLAND
Booster
Balíček obsahuje: prémiovou fóliovou kartu s náhodně zvolenou úrovní vzácnosti, 2 vzácné (nebo vzácnější) karty, 3 neobvyklé karty, 6 běžných karet a Lore kartu. Rozměry balení: 12,1 × 6,6 cm.









GN633001 169,- 139,-

















Zvířátka
GN610892 169,- 129,-










GN635557 379,- 309,-
Star Wars UNLIMITED JUMP TO LIGHTSPEED
Balení obsahuje: 9 běžných karet, 3 neobvyklé karty, vzácnou nebo legendární kartu, velitele, základnu / žeton a fóliovou kartu. Rozměry balení: 12,5 × 6,6 cm.


Pokémon TCG

GN633536 139,- 119,-













SCARLET & VIOLET 09
JOURNEY TOGETHER
Booster



Balení obsahuje: 10 náhodně namíchaných karet. Rozměry balení: 11,6 × 6,4 cm.
GN632299 169,- 139,-










ME ABUBLINA
ME A bo


Balení obsahuje koncentrát Megabublina (1 litr, ze kterého vyrobíte 4 litry bublifuku), bublifuk Megabublina s foukátkem (2 0 ml), 2 plastové kroužky, velkou š ůrku na tvoření obřích bublin a misku na bublifuk. N 999,- ,





ME ABUBLINA
Sada v Balení obsahuje bublifuk Megabublina (2 0 ml), 2 kroužky, 2 látkové potahy, misku na bublifuk a trubičku na menší bubliny.







Sta se zvídavým paleontologem a objev spolu s Igráčkem dávno vyhynulé dinosaury. S pomocí paleontologického náčiní vykopej ze dvou kamenů kostry dinosaurů. ra je vhodná pro děti od let. Rozměry balení 14,7 1 ,9 , cm.



N Triceratops a Brachiosaurus paleontolo 229,- , N T ranosaurus a Ste osaurus paleontolo 229,- , N Parasaurolophus a Diplodocus paleontolož a 229,- ,












Sada je vhodná pro děti od 4 let.
Brož., 24 stran t to a , 2 ,3 × 27,7 cm


























N 3 9,- ,
Omalovánky obsahují 24 barevných stran s obrázky k vybarvení a 2 listy s originálními tetovačkami různých velikostí a tvarů.


N Víl a prince n 139,- , N Zvířát a 139,- ,














Sešit obsahuje 24 kouzelných obrázků, k jejichž vybarvení dětem stačí pouze štětec a pár kapek vody. Omalovánky jsou vhodné pro děti od 3 let. Brož., 24 stran, 22 × 29 cm
N ar a 1 9,- ,




N Zoo 1 9,- ,






Kores
SET ŠKOLNÍCH POTŘEB V KUFŘÍKU



Jedinečný set pro každého školáka! Kufřík obsahuje: lepicí tyčinku, pastelky, plastelínu, vodové barvy, gumu, tužku, temperové barvy, papírové pravítko, záložku a dva rozvrhy hodin. Rozměry balení: 36,4 × 23,8 × 6,5 cm.





BASILUR
Cold Brew





TERMOHRNEK





Praktický cestovní hrnek se šroubovací horní částí a odklápěcím víčkem. Materiál hrnku: nerezová ocel, objem: 320 ml, výška: 12 cm.










GN619246 Kočky 669,- 539,-



GN619245 Ptáčci 669,- 539,-




GN552563 499,- 399,-














Směs ovocných ledových čajů (60× 2 g): Guava & Passionfruit, Coconut & Pineapple, Strawberry Cucumber & Mint, Pomegranate & Blueberry, Cherry & Lime a Orange & Mango.

GN550752 299,- 239,-
BASILUR
Blue Tea
Dárková kazeta obsahuje zelené čaje s modrými nálevy (40 sáčků, 60 g). Vychutnejte si levanduli s borůvkou, bílou růži s vanilkou, lotos s jablkem a bezový květ s pomerančem.





VELKÝ KOUPELOVÝ SET SWEET PEONY
Dárková krabička obsahuje: sprchový gel (180 ml), tělové mléko (180 ml), tělové máslo (60 ml) a síťovanou houbu (10 g). Vůně: sladká pivoňka. Rozměry balení: 21,5 × 15,9 × 7,9 cm.
KOUPELOVÝ SET SWEET PEONY V PAPÍROVÉ KRABIČCE
Balení obsahuje: sprchový gel (100 ml) a tělové mléko (100 ml). Vůně: sladká pivoňka. Rozměry balení: 10,2 × 11,5 × 5,6 cm.


GN604664 239,- 189,-
GN632930 149,- 119,-





GN632931 329,- 269,-








Jsme tu pro vás v knihkupectvích LUXOR . Po předložení zákaznické karty
Knižního klubu PREMIUM získáváte 20% slevu na knihy nakladatelství Euromedia a 5% slevu na tituly z ostatních nakladatelství a neknižní zboží.
BRNO NC Královo Pole, Cimburkova 593/4 tel.: 722 360 393 lympia Brno, U Dálnice tel.: 1 2 0 3 3
B ECLAV Sady 28. října 431 1 a tel.: 519 3 1 4 3
ESKÉ B DĚ OVICE U Černé věže 15 tel.: 389 058 910-1 Čtyři Dvory, Milady Horákové 1498 tel.: 380 0 0 18
R DEK-MÍSTEK Frýda, Na Příkopě 3 2 tel.: 59 490 993
HRADEC KRÁLOVÉ Futurum, Brněnská 1825 23a tel.: 498 501 110
CHOM TOV homutovka, Dr. Farského 4 32 tel.: 41 419 920-1
CHR DIM iroká 11 tel.: 30 514 451
IHLAVA itypark, Hradební 1 tel.: 5 0 004
KARLOVY VARY T. . Masaryka 854 25 tel.: 31 451 345
KLADNO entral ladno, Petra Bezruče 3388 tel.: 321 338 985
LIBEREC Forum, Soukenné nám. 9 2a tel.: 48 919 940-1
MLADÁ BOLESLAV Bondy entrum, tř. Václava lementa 1459 tel.: 32 509 9 0-1
OLOMO C alerie Moritz, 8. května 4 5 24 tel.: 58 301 830-1
OPAVA Breda einstein, U Fortny 49 10 tel.: 558 889 820-1
OSTRAVA Avion Shopping Park, udná 114 3114 tel.: 59 490 990-1 Forum Nová arolina, Jantarová 3344 4 tel.: 1 253 531
PARD BICE Palác Magnum, Třída Míru 2800 tel.: 24 3 2 158
PL E Plzeň Plaza, adčická 28 1 2 tel.: 3 8 229 930-1
PRAHA uadrio, Spálená 2121 22 tel.: 29 110 01 Václavské nám. 41, 1. patro tel.: 29 110 3 9 N Palladium, nám. epubliky 1 tel.: 29 110 100
PRAHA Hlavní nádraží, ilsonova 300 8 tel.: 29 110 405
PRAHA 3 Atrium Flora, Vinohradská 151 2828 tel.: 29 110 800
PRAHA 4 estfield hodov, oztylská 2321 19, 1. patro tel.: 29 110 50
Novodvorská Plaza, Novodvorská 1800 13 tel.: 29 110 45 DB , Budějovická 1 4 tel.: 29 110 450-1
PRAHA 5 Nový Smíchov, Plzeňská 8 tel.: 29 110 411
PRAHA 6 metro Dejvická, vropská 1500 1 tel.: 29 110 00
PRAHA 9 alerie Harfa, Českomoravská 2420 15a tel.: 29 110 4 0
PRAHA 0 uropark těrboholy, Nákupní 389 3 tel.: 29 110 500-1
PRAHA epy, Makovského 1349 2a tel.: 29 110 1
P EROV alerie Přerov, Čechova 3491 2 tel.: 1 2 0 810
TÁBOR D Dvořák, 9. května 288 tel.: 381 251 8
TEPLICE N Fontána, náměstí Svobody 3312 tel.: 1 515 943
STÍ NAD LABEM Mírové náměstí 10 30 tel.: 5 858 35
LÍN laté jablko, nám. Míru 1 4 tel.: 5 201 901
Otevírací dobu knihkupectví najdete na www.knizniklub.cz/prodejny.


Stáhněte si aplikaci










M J LUXOR














































































































































Knižní klub vám přináší spoustu výhod!
Na .knizniklub.cz nebo objednávkou přes zákaznický servis můžete nakupovat s minimálně 20 slevou z běžné ceny. Vybírat můžete z více než 1 0 000 titulů.
V knihkupectvích U získáváte trvale 20 slevu na tituly nakladatelství uromedia a 5 slevu na ostatní tituly a neknižní sortiment.
• 5 × ročně zdarma klubový katalog.
Pravidelné akční slevy, slevy k svátku a narozeninám, slevové poukázky a výprodeje.
Jak si udržíte všechny tyto výhody? Stačí si nakoupit 5 knih ročně, ideálně v období platnosti každého katalogu jeden titul. Více o pravidlech členství naleznete v P L OR K PREMI M na .knizniklub.cz.
Dostanete-li nedopatřením vadné výtisky nebo jiné než objednané knihy, pošlete je co nejdříve s kopií dodacího listu poštou nikoli na dobírku zpět na adresu: uromedia roup, a. s. reklamace M zásilek, svobození 535, 2 3 03, Stochov. Na této adrese není možné vyřídit reklamaci zboží osobně. Uve te prosím objednací číslo požadovaného titulu. Vámi objednaný titul vám zašleme obratem.
boží zakoupené přes internet nebo pomocí zákaznického servisu máte právo do 14 dnů od jeho převzetí vrátit. Toto právo neplatí u audionahrávek a videonahrávek, pokud jste porušili jejich originální obal.
V případě, že dojde mezi námi a spotřebitelem ke vzniku spotřebitelského sporu z kupní smlouvy nebo ze smlouvy o poskytování služeb, který se nepodaří vyřešit vzájemnou dohodou, může spotřebitel podat návrh na mimosoudní řešení takového sporu určenému subjektu mimosoudního řešení spotřebitelských sporů, kterým je Česká obchodní inspekce. Více informací naleznete na .knizniklub.cz v sekci bchodní podmínky.

Objednávky
226 289 262 www.knizniklub.cz
Po–Pá 8–18 hod. info@knizniklub.cz íslo tu p o 2113348520/2700
Kolik aplatíte a dop avu
DOPRAVCE
Česká pošta Balíkovna na adresu
Česká pošta Balíkovna výdejní místa
PP výdejní místa
PP kurýrní služba
ásilkovna výdejní místa
ásilkovna kurýrní služba
D kurýrní služba
D 999 K

latnost katalo
kata o eden b e en kata o duben k ten kata o če en s en kata o í íjen kata o N isto ad osinec
ledu te nás na sociálních sítích!


výhradně v knihkupectvích U na tituly nakladatelství uromedia při předložení karty nižního klubu P MIUM a do kladu totožnosti pro kontrolu data narození . Tuto slevu nelze kombinovat s jinými slevovými akcemi, lze ji použít pouze










Papež František
NADĚ E
Autobiografie










V této výjimečné knize se papež František ohlíží za svým pozoruhodným životem, přibližuje své dětství i dospívání a události, které ho přivedly k volbě životního poslání. S moudrým nadhledem a laskavým humorem odhaluje střípky z osobního života i rodinné historie. Upřímně a s odvahou se věnuje výzvám, jimž musel čelit během svého pontifikátu, včetně zásadních témat, jako je válka, migrace či postavení žen. Váz., 328 stran, 14,5 × 22,7 cm
GN045549
nižní klub
Nádražní 2 32
150 00 Praha 5




499,- 399,-


atalog nižního klubu vydává U M DIA UP, a. s. IČ 49 09895 egistrační č. M Č 13888
F ANTI

Tisk: Severotisk s. r. o., stí nad abem edakce: H. Hříbková rafická prava a foto: A. Pa ková a M. Slezáková Právo na tiskové chyby vyhrazeno. V knihkupectvích U není z kapacitních důvodů k dispozici kompletní sortiment z tohoto katalogu. Nabídka platí pouze do vyprodání zásob.
